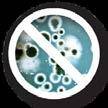

![]()









Address: 379 Docklands Drive, Docklands VIC 3008
Phone: 03 9690 8766
Email: editor@bigrigs.com.au
Web: bigrigs.com.au
Accounts: 03 9690 8766
Subscriptions: 03 9690 8766
Classifieds: 0403 626 353
Circulation and distribution
queries: 03 9690 8766 info@bigrigs.com.au
EDITOR
James Graham: 0478 546 462

SHOCKING crash statis-
tics on the Bruce Highway highlight the need for urgent action, says the RACQ.
james.graham@primecreative.com.au
REPORTERS
Danielle Gullaci 0478 844 797
danielle.gullaci@primecreative.com.au
Kayla Walsh 0401 551 494
kayla.walsh@primecreative.com.au
DESIGN
Daz Woolley – Art Director
Alejandro Molano - Art Director
GENERAL MANAGER
Peter Hockings: 0410 334 371 peter.hockings@primecreative.com.au
BUSINESS DEVELOPMENT
MANAGER
Treena Heit: 0403 626 353
treena.heit@primecreative.com.au
CLIENT SUCCESS
Katharine Causer: 0423 055 787
katharine.causer@primecreative.com.au
CONTRIBUTORS
Truckin in the Topics/Spy on the Road: Alf Wilson, 0408 009 301
David Vile, Graham Harsant, Geoff Middleton and Jonathan Wallis.
Big Rigs National Road Transport Newspaper is published by Prime Creative Media. It is the largest circulated fortnightly truck publication in Australia with 22,500* copies per fortnight.
*12 month average, October 2022
RACQ has joined forces with leading Queensland organisations, including the Queensland Trucking Association, to fight for a better Bruce Highway, with new data revealing it has an average fatal and serious injury (FSI) crash rate three to five times higher than major national highways in NSW and Victoria.
“The Bruce Highway is the backbone of this state, it’s supposed to be a national highway but when you compare it to the Pacific or Hume, it’s substandard,” said RACQ managing director and CEO David Carter at the recent launch of a new Fix the Bruce campaign.
“Those interstate highways have rightfully been upgraded to three, four and five stars out of five for infrastructure safety, yet around half of the Bruce is still a poor two-star rating. In 2024, there is no way Queensland should have any two-star sections on the Bruce Highway.
“We know proper upgrades work and safer roads save lives.
The Cooroy to Curra section
of the Bruce Highway, which is now dual carriageway, has a similar FSI crash rate to rural sections of the Pacific and Hume, which means it’s five times lower than the single lane, undivided sections of the Bruce.”
In a statement, federal Minister for Instructure Catherine King told Big Rigs that the federal government is investing $10 billion on the Bruce Highway, including $1.35 billion for the Bruce Highway Safety Package.
King said the latter goes directly to areas that need it most.
“We have a significant amount of money on the table, and now the work needs to be done,” King said.
“I have asked that the Queensland government bring forward proposals to accelerate safety works, within Commonwealth commitments already made as well as future priorities for the upcoming budget process.”
When asked about the likelihood of a dual carriageway north of Gympie, King said the federal government works closely with the state government on projects they deem a priority.
“Should the Queensland


government identify this as a priority for federal funding, we will consider any proposal through the usual budget process.”
While the Albanese government is sticking with the original 80:20 investment split with the state government for the Inland Freight Route, any future projects on the Bruce are likely to be via a 50:50 funding split.
“What we are asking is that, moving forward, the states match our commitment on jointly-funded projects; Not
to increase what they invest in infrastructure overall, but to spread their funding more evenly on the projects we fund together in order to share in risk and have healthier incentive to keep costs in check,” King said.
Earlier this year, the state government released details of its 15-year plan for the Bruce which included flood immunity projects, bridge replacements and the Rocky Ring Road
The Miles government said it will also increase its annual
Bruce funding commitment to $250 million a year from 2027-28.
A damning report by Northern Bruce Action Group member Colin Dwyer and Dr Tracy Cheffins, who drove more than 1600km along the highway in July, said the Bruce would need $20 billion to bring it up to par.
Local MP Andrew Willcox said the section that runs through his Dawson electorate is the most dangerous and has started a petition, Back Our Bruce, to lobby for fixes.




A spate of truck crashes on Queensland’s major freight route has added more weight to industry lobbying for urgent safety fixes.
Speaking after a horror run of accidents in late August, which saw three people lose their lives and an explosion that blocked the route for five days, the CEO of the Queensland Trucking Association, Gary Mahon, said the federal government must do more to make the Bruce Highway safer.
“The bottom line is, it’s time for a significant upgrade in investment,” said Mahon.
“When you consider that it’s
the only number one highway in the country that is not multi-laned.
“The three main highways in NSW are multi-laned, as are a couple in Victoria.”
To illustrate how slow progress has been on getting the Bruce up to par, Mahon cited the Cooroy to Curra upgrades, a 62km Gympie bypass, that has taken 15 years to finish.
“There’s another 1398km to go from Gympie to Cairns,” Mahon said.
“We know where the treatments are needed; bridge replacements, pavement widths, overtaking lanes, rest areas,

floodway treatments, and the like.
“We’re going to need a boost to something like $15-$18 billion over the next 6-8 years, but that would bring it up on those single lane sections from two-star to three-star.
“Over time the more substantial investment to multi-laning will occur over how many next decades it’s going to take.”
Mahon argues that it all comes down to what he calls “the will and desire” of government.
“To shift the priority on to that level of investment,” he said.
“In areas where they want to, they find that sort of money. What we’re saying is, it’s time that the Bruce got its turn.”
Mahon said there are no shortage of sections of the Bruce that need fixing: “it’s almost an endless list.”
There are a raft of dangerous intersections at Maryborough – the scene of a horrific fatal crash in March – and he also singled out the Marlborough stretch that gets a lot of mentions by drivers.
“There are literally tens of bridges that are too narrow

and bridges that are lacking in capacity in any case. I also believe there are only two or three overtaking lanes between Rockhampton and Mackay.
Mahon also understands that there is planning for ring roads around Childers and Gin Gin, but now it’s a matter of finding the money to make it happen.
“The Tiaro bypass is about to commence, but we’ve not had any formal feedback about provision of rest areas along that section.”
Mahon said the fact that the spate of accidents on the Bruce in August all occurred within about 60km of each other also highlights the need for urgent fixes in that region.
“All through that section the shoulder width is negligible. So, you have a situation where drivers are getting along there at night, with virtually no shoulder something happens in front of them, or sudden loss of visibility, like we had last week [August] with fog and smoke, they can’t pull over without becoming a hazard themselves.
“That’s the sort of concern that we have right up and down that highway, because
Mahon said it’s great that the Rocky Ring Road has started but the rate at which the Gympie Bypass was finished, is a concern when you look at the relative speed it took to duplicate the Pacific Motorway.
“Multi-laning, or duplicating, fundamentally eliminates just a tremendous outcome for that sort of level of capital investment. It’s also an enormous economic boost, improved safety, connectivity, productivity, you know, reli ability during all weather.”
Mahon said completion of the Inland Freight Route will take the pressure off the Bruce, with a number of works already underway on the 1185km route from Mungindi to Charters Tow ers.
“But you’re still going to have what we’d call the retail freight on the Bruce deliver ing into those communities, and the amount of vehicles out every night is in the hun dreds.”
government to fix the Bruce.
“We’re very concerned that the federal government has stepped back from an 80:20 funding distribution [with the state] to 50:50 on the Bruce and that’s not reasonable in our view.
“It is the number one road and part of the national highway network. I don’t think it’s unreasonable to expect that our federal government steps up and sticks to the 80:20

The QTA has now joined a consortium of other industry groups, that includes the RACQ, to lobby political

Ryco’s N99 Commercial Cabin Filter range is designed and tested in Australia’s only dedicated filtration laboratory to meet the harshest Australian conditions.
Protect your HVAC system with a Ryco N99 Cabin Air Filter.
Contact Ryco to discuss your fleet’s requirements at fleetsupport@rycofilters.com.
So, when your fleet needs superior filtration, be Ryco Ready.







operator Michael Mahon fears that unless the Bruce black spots are fixed, operators’ on-going battle to find drivers will only get tougher.
The director of MJ Mahon Transport, specialists in refrigerated transport, sends between 15-20 trucks north on the Bruce every day.
His drivers were all first on the scene at each of the three truck crashes that occurred in a nightmare week on the Bruce last month that also claimed two lives and shut the highway down for an unprecedented five days.
“We’re going to get to the stage where drivers are just not going to want to drive on the Bruce Highway,” said Mahon, the president of the Queensland Trucking Association.
“We’re going to get truck drivers who are going to say, ‘I don’t want to travel north, I just want to travel south. I can sit on the M1 and listen to my podcast and have my cruise control’.
“I think all of a sudden, the transport companies based here and in North Queensland, we’re going to get to the stage where drivers

are going to say, ‘You’re going up the Bruce? No, that’s not for me’, and we’re going to have a shortage of drivers, which then impacts on costs, and so on.”
“That’s my longer-term concern.”
Adding to Mahon’s frustration over the current dangers on the Bruce, is that there doesn’t appear to be any plan to fix them.
“So, we can’t go to our driver group and go, ‘Hey guys, this is the plan, and this is how we’re fixing it, and this is what it’s going to look like in the future.
“There’s all this growth in all these cities but no one is actually laying the road infrastructure out to service it.”
Mahon said the Bruce, widely derided now as ‘the goat track’ among many in the industry, is just not up to the level it needs to be.
“When you look at your class one highways in NSW and Victoria, multi-lane for the entire distance. I understand that Queensland’s double the distance, but we’ve really only got a class 1 highway until Gympie.”
Mahon says it’s hard to pinpoint one area on the Bruce

over another that he’d prior itise for immediate attention, there are just so many trouble spots.
He cited the sections around Maryborough as “notorious”, near the recent accident sites, south of Benaraby, Miriam Vale, Gin Gin, and also the stretch between Mackay and Townsville.
His business at present doesn’t service north of Townsville, but recent feedback he got from operators who do, described the Bruce between Townsville and Cairns as “horrendous”.
As we were going to print with this issue, Mahon was relieved to hear that at least the closed section of the Bruce near the blast site south of Gladstone was finally reopening, albeit partially.
After the first incident major incident at Gindoran in which low visibility from fog and smoke contributed to a multi-vehicle crash that claimed the life of a 29-yearold truckie, Mahon temporarily grounded his entire fleet for the first time in nearly 25 years of operation.
He was full of praise for the patience and skills of all drivers forced to take the resulting

detours and cope with the increased traffic.
Mahon reserved a special mention for his staff drivers who rushed to the aid of those trapped in the wrecks without a moment’s thought for their own safety.
“They’re racing into scenes with DG, in both cases, to help fellow truck drivers, and cars as well,” said Mahon, who is planning a special commendation in acknowledgment.
“They’re just straight in there with fire extinguishers









trying to save their brothers, the truck drivers who are out there with them every day and night, and other road users –they’re heroic efforts.
“I think as an industry, and society, we do need to recognise these guys and support them.
“Support them in terms of what they’ve seen and had to deal with, and longer term, we need to recognise their efforts and say, ‘You know what, you guys went above and beyond’. “I’m proud of them.”




BY ALF WILSON
FOR decades truck drivers have been calling for a major upgrade of the Bruce High way.
After a spate of recent acci dents some of which included trucks, the call for action has never been stronger.
Gary Snell, aged 62, works for Todd Wiltons Transport in southern Queensland and has been driving along the Bruce Highway for 43 years.

Speaking to Big Rigs while tending to his trailers at a roadhouse, Snell was scathing in his criticism of the Bruce Highway.
“The section between Gin Gin and Gympie is an absolute disgrace and when they do work on it is just a temporary fix,” Snell said.
That was not the only stretch which Snell said was dangerous and unsafe.
“Between Sarina and Rockhampton it is also bad in some parts and Townsville to Cairns section is dangerous and has lots of potholes. It is especially difficult in wet weather and it rains a lot up there,” he said.
Dave Morgan is the owner of the busy Bohle-based
Morgan Transport which has 60 trucks.

Each day, his fleet travels the Townsville to Cairns run and also from Townsville to Mackay.
Morgan Transport also has three trucks which carry general freight daily from Brisbane to Townsville.
Morgan said he recently he travelled in a company truck with operations manager Cameron Wright and was disgusted with the state of the highway.
“North of Rockhampton it is horrendous, and we had to slow down to 60km/h so the truck wasn’t damaged,”
suffered “premature damage” because of the rough highway.
“This is tyre and suspension damage,” he said.
Morgan said his drivers reported that highway around Marlborough was especially difficult.
Veteran 72-year-old truckie
Laurie Seery has been driving the Bruce Highway since 1980 and described it as a “goat track like some in third world countries’’.
“It is a major Australian road and the food chain route from north to south and hasn’t improved much over the years,” Seery said.
SYDNEY
510 Victoria Street, Wetherill Park NSW 2164 Ph. 02 9756 6199, email: isri@isri.com.au, www.isri.com.au
BRISBANE


and it needs to be fixed. There are not enough passing lanes which is a safety issue,” he said.
I asked Seery what he considered the worst sections and he said there were many.
“Around Gin Gin it is a disgrace and between Cairns and Townsville it is not good. There are potholes galore. Also, down to Mackay it is shocking in places,” he said.
Seery said he would recommend to authorities who send up engineers from Brisbane to draw up plans to upgrade sections to consult with locals.
“The locals know where the
water runs and where it can cross the highway and close it after rain and their advice should be taken,” he said.
Sarina-based Chris Hodgkin, 38, who was sitting in the driver’s seat of a Mack Titan when I saw him, works for Sarina Crane Hire and is a relative newcomer to the industry but travels the Bruce regularly.
“Sarina to Rockhampton is terrible at many places especially along the Marlborough stretch. There are ruts along it and also fog early on and that adds to it,” he said. Bruce was in the cabin of a
yellow Kenworth parked up in Townsville and didn’t want his surname mentioned or picture taken, but was highly critical of the route.
“I have been driving for 35 years and try and dodge driving along the Bruce unless I have to. I use the back roads where I can,” he said. I asked Bruce what he considered the worst parts when he does have to use it.
“Where do I start? Most of the Bruce Highway is buggered,” he said.
Turn to page 6 for more driver reaction


3/120 Gardens Drive, Willawong QLD 4110 Ph. 07 3275 2044, email: sales@isribrisbane.com.au, www.isribrisbane.com.au
MELBOURNE
Unit 1/569 Somerville Rd, Sunshine West VIC, 3020 Ph. 03 9311 5544, email: sales@isrisunshine.com.au, www.isri.com.au
MACKAY
110 – 120 Maggiolo Drive, Paget QLD 4740 Ph. 07 4952 1844, email: admin@isrimky.com.au, www.isriseatsmackay.com.au
PERTH
408 Welshpool Rd, Welshpool WA 6106
Ph. 08 9362 6800, email: info@mmtisri.com.au, www.mmtisri.com.au
DARWIN
Mobile Sales and Service
Ph. 08 8927 0986, email: info@isridarwin.com.au, www.isridarwin.com.au
ADELAIDE
TAMDELE, 21 Hakkinen Road, Wingfield SA 5013
Ph. 08 8347 1222, email: sales@gitsham.com.au, www.gitsham.com.au
NEWCASTLE/HUNTER VALLEY
Unit 2/13 Hinkler Ave, Rutherford NSW 2320
Ph 02 4932 0600, email: sales@hvss.com.au www.isri.com.au














BY KAYLA WALSH
A former truckie has told how he quit the transport industry after witnessing too many accidents on the “goat track” that is the Bruce Highway.
Richard Walker, 39, walked away from trucking about a year and a half ago, after he and his partner welcomed their first child.
“I was working for a great company, running Far North Queensland up to Cairns and back inland,” he said.
“I was enjoying it, but there were so many accidents on the Bruce, and I had so many close calls.
“I started questioning whether I’d make it home or not every time I got in the truck.
“One day my partner sent me a video of our son laughing for

the first time, and that’s when I knew I couldn’t keep doing this to myself or my family.”
There were a few accidents in particular that prompted Walker to hang up his keys.
“I have been on the scene of multiple fatalities and traffic accidents over the years,” he continued.
“I stopped not long after seeing the aftermath of an accident near Home Hill.
“There were two people in their 60s who were clipped by a stolen vehicle and sent in front of a B-double that absolutely obliterated the car.
“It was so gruesome, it really shook me.”
The Brisbane man said that while dangerous driver behaviour contributes to crashes on the Bruce, fixing the highway would make a huge difference.
“I am always saying this, and so is every driver that has to run that goat track – many of these accidents could easily have been avoided.
“How much blood has to be soaked into that highway before the government actually pull their finger out and do what needs to be done?
“How much is a life worth to them?”
“We need a dual lane all


the way to Cairns, but I don’t think I’m going to see that in my lifetime.”
Walker thinks the Queensland and federal governments should also invest in building bypasses.
“If I was in charge, the first thing I would do would be very similar to the Sydney idea.
“I know no government has
got $6 billion lying around, and the Bruce Highway is twice as long.
“But I would find alternative tracks, I’d go a little more inland, and I would bypass as many towns as possible –especially the section from Childers to Maryvale.
“I think that is the most dangerous section of the highway.”
dustry.
“I got into driving kind of by default, because I wasn’t very good in school,” he said.
“I saw it as an avenue to provide an honest living, and I liked the freedom it offered, but I really lost my passion for it over the years.
“No job is worth your life, and since I started as a professional driver, the odds haven’t gotten better.”
Walker is in the process of starting his own business, and he’s excited about spending more time at home.
“The past few months I’ve been able to spend much more time with my son, I’ve really gotten to know him again,” he said.
“I can’t wait to watch him grow up.”
BY DANIELLE GULLACI
A second-generation truckie on the road for the past 35 years, 54-year-old Michael Hogg works for Morgan Transport Group, mainly pulling B-doubles from behind the wheel of a DAF.
He does the approximately 970km run from Brisbane to Mackay, travelling along the Bruce Highway.
Hogg says the condition of the road is getting worse and worse and is calling on governments to do something about it.
“I think what the govern-
ment needs to do is get their heads together, start from the Gympie Bypass and then keep moving north, making it a dual carriageway,” he said.
“It might take another 30 years to complete, but at least then people can see something is being done.”
In Hogg’s view, the worst stretches of the Bruce Highway that he travels are from Gin Gin to Miriam Vale, and from Marlborough to Mackay. “The road is pretty average and there are a lot of incidents. I wouldn’t call it corrugated but the road is wavy enough that you get thrown
out of your seat!
“If I go into a workplace, there are things in place to protect me – but for truck drivers, look at the condition of the Bruce Highway. It’s been neglected and the government expects us to travel on it.
“Roads are being built to a budget and not a standard and projects need to be done more quickly.
“If the government says we’re going to put $100 billion into the Bruce, we all say, okay but what’s the catch. People have become cynical.”
Compounding the issue, he
says, is that heavier vehicles are being put on a highway that’s already not up to standard.
“I’m all for productivity and more freight with less vehicles, but at the end of the day, the roads need to be fixed,” Hogg said.
“The road is already crappy and then these big companies are paying a permit to allow larger vehicles on the road, when it’s already struggling to cope with B-doubles.”
And then add to that driver education. “People do need to learn to drive properly on these roads,” said Hogg. “We need to also educate people to
have more respect on the highway – and patience.
“The Bruce Highway has been nicknamed the Death Highway and if something isn’t done, more people are going to die.
“I have so much emotion for that truck driver who didn’t come home after that recent incident. His family has been torn apart for the rest of their lives.
“We have partners at home worrying. The government makes these promises for the next 30 years, they keep blaming each other and at end of the day nothing gets done.”


WE asked the nation’s truckies what they thought were the biggest safety issues on the Bruce Highway and how we could fix them. Here’s what a few of you had to say to our callout on the On The Pads Queensland Facebook group.
Niell Graham
Mackay to Proserpine needs urgent attention. It needs to be straightened out and it needs more overtaking lanes and better signage to tell drivers that it’s a 100 zone. Too many people do 80 or less
on that stretch but seem to be able to do 100 when we want to overtake them which causes people to do stupid things to get round slow drivers. also the stretch between Innisfail and Gordonvale is the same narrow width and most people do 80 and the biggest hazard has to be when the army is out and about. If they want to travel at 80 they can but they should have a UHF on them so we can communicate with them as when you get 8-10 vehicles doing 80 in convoy it makes it hard to get past them all.
Jon No
They need to actually fix it, not Band-Aid it and four lanes the whole way up!
By the time they fix a pothole it’s opened up to a crater and they slap some shit in it and move on. It’s never fixed properly so by the time it rains again it’s back open. The volume of traffic and it being a main route you would think they would put a bit more effort in. Times have changed since it was first built. The roads are heaps busier and that needs to be accommodated. Another massive part is incompetence of drivers not taking their time and driving to conditions. The simplest thing like turning your headlights on in foggy/ wet weather seems a hard task to accomplish by some nowadays.
Trevor Warner
The most critical sections that require attention would be between:
• Appletree Creek and Gin Gin.
• Miriam Vale to Midgee Creek.
• Rockhampton to Sarina
It is just a matter of time before there is a huge head-on on the narrow bridges all the way up the coast.
Jaiden Worth
The problem is they “fix” sections that fall apart during the next rainfall. A prime example of that is near Childers. Or they build a new section of road next to the existing at Maryborough, then tear up the old section still leaving it single lane when they had the perfect opportunity to create a dual lane divided section. The Rocky Ring Road won’t be complete until 2031 for a 17km section of road however NSW had Woolgoolga to Ballina (155km) done in five years. It makes Queensland seem like a bit of a joke in comparison.
Mark Hopper
Yep, there are worse roads out there, but they aren’t Highway Number 1. I can guarantee you the volume of traffic isn’t as it is on the Bruce. The simple answer is the road can no longer handle the volume of traffic.
Rod Nott
Gin Gin to Mackay [is the worst] but the Ausroads standard is a joke. This needs to change then bring the road up to a higher standard. I also disagree with people blaming other drivers. Statistics show you are five times more likely to be injured on the Bruce track as the motorway between Brisbane and Sydney. Same drivers different road
Patrick Waters
It needs to be replicated dual lanes all the way from Brisbane to Cairns. It will reduce the accidents a lot. The traffic use on that highway has out grown the road for it being single lanes each way
Barry Sheppard
I was on the Bruce in a truck from 1988 to 2005. The improvements I have seen since about 1990 have been fantastic; heaps of bypasses (Wallaville, Maryborough, Gunalda Range, Cooroy, Nambour ) and a lot of widening and straightening of the road, that’s just from Gladstone down to Brisbane. There is
always more to do to every road. In my experience I believe that there are two major things that need to happen. Number one: lift the speed to 110km/h. It seem that people are happy at 110; there seems to be less need to overtake people. Just follow along behind each other. The speed limit was originally set at 60 mph which is 100km/h with old FJ Holdens that were not the greatest handling cars on single lane bitumen roads. We now have dual lane carriage ways with cars that respond much better.
Number two: is driver education and a much more advanced driver training and testing. People learning to drive from people that are not good drivers themselves need to stop. Going from a body truck to a B-double in a 10-hour course is a disaster and then the following day add a dangerous goods ticket and we have a truck going up the road with explosives and the driver has been in an articulated truck with less than 10 hours’ experience.




EDITOR
JAMES GRAHAM
This transplanted Kiwi on his first road trip north thought he’d taken the wrong turn and ended up on a regional B-road.
I remember saying to the wife: “The main highway must be further inland. No way our truckies have to drive on this all the way up to Cairns.”
The tragic spate of accidents on the highway in recent weeks have only underlined just how much work there is still to do to bring this national highway up to scratch.
While the federal government ducks for cover on a resumption of the old 80:20 funding arrangement, the Miles state government spits out media releases on floodproofing and Band-Aid patchups. With the vast majority of electorates in the metro southeast, what are the odds of the cries for a dual carriageway ever being answered?

Truckies had a strong reaction to Jodie Broadbent’s recent column explaining what happens inside the 100km radius when it comes to fatigue rules.
Many said the rules were impractical and unfair, with Simba Bass writing on the Big Rigs Facebook page: “What are the obligations for a person slogging it out all day, then jumping in his or her car and driving as far and wide as they like? What’s to say that person’s not going to doze off behind the wheel and drift into oncoming traffic? There shouldn’t be any obligation
within the 100km radius.”
Darrell Clark added: “The same questions get asked when tourists come in off a long-haul flight, hire a rental car and head off on a three-tofour-hour drive.”
Others thought fatigue rules would make drivers want to quit the industry.
“Geez, I don’t know why people don’t want to drive trucks anymore,” Paul Ryan quipped.
Mark McCann agreed: “That is why I left the industry after over 30 years. Saw the bullshit on the wall. Sad really.”

adobe.com.

A recent opinion piece by
a
In the strongly-worded piece, Dumesny argued that
road safety academics need to try harder, and start actually talking to truckies – and most of our readers agreed with him.
“Absolutely - speak with those of us training/instructing/licencing the next generation of
drivers too,” wrote Ashleigh Anderson.
John Williams chimed in:
“Start talking to drivers that have been on the road for 20 years in all variants of the job and start employing them to make the way forward.”
“The road safety academics need to get out here and see for themselves,” said Dave Cowan.
Craig Masefield argued that all of the trucking associations, plus the state and federal transport ministers, need to start listening to the nation’s truckies.
“They are the ones on the front line, not some uni-graduate that knows nothing about what happens out on the highways of Australia,” he said.
Outback Truckers is back on our screens after a three-year wait, and our readers seem pretty happy about it.
In response to a Big Rigs story about its return, Ian McLaren wrote: “It was great to see this back on air. Particularly good to see Sludge back in The Phantom, even if it was only in the passenger seat.”
“Love it and about time!” added Bob Bohdan. “Miss the old Steve and the crew.”
Dianne Ellis echoed: “Great to see Steve and Sludge last night. Had to laugh at Sludge’s wife getting upset with him, just like us.”
Others weren’t keen on the idea of watching a TV show

about trucking after being in a truck all day long.
“If you have to watch trucking on the TV after trucking l day, you ain’t working hard

A recent story about the NHVR nabbing an operator for transporting dangerous goods alongside food got a big reaction from our readers. Loaves of bread were stored alongside hypochlorite solution in a two-axle rigid truck
intercepted by the regulator, with no separation and no safety equipment on board.
Stelios Papoutsidis said: “It’s great to see that the NHVR actually went after the operator and didn’t just shaft the driver for everything. That said, the driver should be
enough,” said Luke Hayden. “F*ck being in the truck all day then coming home and watching trucks on the TV,” Tommy Ryan agreed.
made to complete a course for DG. With a severe lack of knowledge of even basic restraint of load, let alone dangerous goods on their part, it ma kes a dangerous combo to go with the negligence of the operator.”
“Serves him right,” added Russell Holley. Other commenters had some harsh words for the NHVR.
“Took them 10 years, finally doing the job they set out to do,” said Curtis Riley.
Meanwhile James Atkins joked: “Have some battery acid with your ham sandwich.”

BY DANIELLE GULLACI
QUBE has announced the acquisition of Western Australia based Coleman’s Transport, as part of a move to expand its capabilities in the west’s booming mining sector.
Coleman’s Transport is an integrated transport, logistics and storage business involved in the Security Sensitive Ammonium Nitrate (SSAN) supply chain in WA.
SSAN is one of the predominant explosives used on mine sites for commodities such as iron ore, lithium, nickel and zinc.
Speaking with Big Rigs, Qube revealed its latest acquisition will include the company’s high security storage sheds located in WA mining centres, including Kalgoorlie, Port Hedland, Wyndham and Kwinana – representing approximately $90 million in assets – and its truck fleet, which includes around 40 double road trains. The total deal is said to be worth $119 million.
“These facilities are close to transport infrastructure, SSAN manufacturing and processing facilities and meet all regulatory and compli-
ance requirements,” said Qube managing director Paul Digney.
While Qube currently has SSAN capabilities on the east coast, this move now expands that into the west.
Qube told Big Rigs that with the acquisition, it will retain the existing Coleman’s workforce, who will now become employees of Qube.
Coleman’s was a family owned and operated business, founded by brothers Robert and Henry Coleman. They had put the business on the market previously in 2015 but failed to secure a buyer.
For Qube, the business was a “natural fit”. Commenting on the Coleman’s deal, Digney added, “This acquisition provides Qube with a platform to enter the Western Australia SSAN supply market and to use its financial and operational capabilities to invest to support further growth and deliver operational improvements for this business.”
The acquisition came into effect on Wednesday August 21, with a transitional period following. In the last financial year, Qube reported a 17.2 per cent revenue growth of $3.5 billion year-on-year.

THE Port of Melbourne will expand into the former Melbourne Markets site, with over $200 million to be invested into its development.
This comes after the Port of Melbourne secured a longterm lease with the Victorian Government of approximately 29 hectares at the site, until 2066, in line with the existing 50-year port privatisation lease.
It’s the port’s largest ever expansion since the long-term lease was granted in 2016.
Container Transport Alliance Australia (CTAA) welcomed the news, saying it’s particularly pleased that the port will invest in developing
CENTURION has expanded its operations into Melbourne, with the opening of a new facility on Somerton Park Drive in Campbellfield.
the site for a range of uses including truck parking facilities and container storage.
The establishment of port functions at the site will help to improve traffic movement in the area, complementing the West Gate Tunnel when it opens. As the largest container port in Australia, CTAA believes the Port of Melbourne needs a state-of-the-art Truck Marshalling Area (TMA), as it is currently the only major capital city port in Australia that doesn’t have one.
“The long-term lease and investment in the old Melbourne Markets site north of Footscray Road provides the perfect opportunity to ad-
dress demand for a well-designed Truck Marshalling Area,” said CTAA in a recent media statement.
“We shouldn’t just aspire to create a ‘low tech’ parking area for truck drivers awaiting their next job in the port.
“We have the opportunity to work with the Port of Melbourne, the container terminals and other container logistics-related facilities in the Swanson Dock precinct (and perhaps even further afield) to link truck arrivals at the TMA to operating systems to give greater visibility of heavy vehicle locations and readiness to be serviced.”
CTAA would like to see the
facility designed to be able to direct trucks to the TMA to await instructions and callup during port congestion or other disruptions.
Container volumes at Port of Melbourne are expected to double by 2050.
Commenting on the expansion announcement, Port of Melbourne CEO Saul Cannon said: “Access to additional land at the former Melbourne Markets site unlocks opportunities that are critical to the future needs of Victoria.
“Port of Melbourne is proud to invest in developing the site to support forecast growth and demands.
“By expanding the Port of

Melbourne’s footprint, it will accommodate more freight and logistics functions at the port, in turn relieving pres-
The location of the new depot is strategically positioned with easy access to major arterial roads.
It will be used as a base for the company’s general freight
According to the company, the move is a pivotal step in connecting Victoria’s industry to regional networks in Northern Territory, South Australia and Queensland. Centurion services clients across the mining, oil and gas, and retail sectors.
and long-haul logistics out of Victoria.
Branch operations manager, Aaron Lake, said: “Our in depth understanding of the local industry allows the team to implement the most cost efficient and effective transport solutions for our customers.”
The new Melbourne de-
Maintain your wheels’ renowned shine effortlessly.
Helps to prevent the build-up of brake dust and discolouring.
There is no danger of harming wheels with abrasive cleaners or chemicals.
Ready to use, no need to dilute. Suitable for weekly use.
Tested and approved by Alcoa Wheels. BUY NOW Available online only


pot offers regional, interstate transport and overflow storage and according to Centurion, is a reputable and reliable one-stop shop solution. Centurion’s national expansion in recent months also included buying the family-owned ABC Transport in Adelaide and Rocky’s Own Transport.



















INDUSTRY groups are lobbying to give more owner-drivers protection under new workplace relations laws.
Under the closing loopholes legislation that came into play from August 26, regulated road transport contractors (RRTC’s), otherwise known as owner-drivers, are now able to apply to the Fair Work Commission to resolve disputes about unfair contracts and unfair terminations.
But at present, that excludes anyone with an income of $175,000 or higher, meaning many owner-drivers with high costs, and tight margins, will miss out on that possible course of action.
It is not currently possible to set different thresholds for different industries.
But in a letter to industry groups, Minister for Employment and Workplace Relations, Senator Murray Watt said government would seek to amend the provisions to allow different thresholds for different purposes.
“I acknowledge your concern that contractors in the road transport industry carry a high level of business costs and a threshold of $175,000 may not be high enough to provide meaningful access to some of the new provisions,” Watt said in the letter.
“When the first opportunity arises, I will seek to amend the provisions to allow different thresholds for different purposes under the Act to ensure all those who should benefit from the new jurisdictions are able to do so.”
Australian Trucking Association (ATA) chair Mark Parry said that it had become clear in the ATA’s consultations with the government that setting a single threshold for all contractors was not workable.
“Road transport contractors face very high business costs, and the figure that is reasonable for our industry is too high to be workable for some other industries,” Parry said.
The Transport Workers’
ROAD TRANSPORT CONTRACTORS FACE VERY HIGH BUSINESS COSTS, AND THE FIGURE THAT IS REASONABLE FOR OUR INDUSTRY IS TOO HIGH TO BE WORKABLE FOR SOME OTHER INDUSTRIES.”
MARK PARRY, ATA CHAIR
Union (TWC) also welcomed a confirmation from Watt that the high-income threshold for road transport contractors will be reviewed and amended at the earliest opportunity.
“It’s encouraging to see that the industry advocacy and consultation with union members and industry groups like ARTIO, NatRoad and the National Road Freighters Association which created this system is continuing to inform the federal government’s decisions on its implementation,” said TWU national secretary Michael Kaine.
“Small business owner-drivers and fleet operators have high costs, yet extremely tight margins. Throughout this process, we have made clear that the threshold must reflect this to ensure the protections are adequate and far-reaching.
“It is crucial that owner-drivers have the confidence to negotiate fair rates and conditions and are able to raise safety concerns without fear of losing work. The transport industry and our economy depend on small business operators being able to carry out their work safely, sustainably and viably.”
In the letter sighted by Big Rigs, Watt also said the earliest a regulated road transport contractor can make an application to the commission under the new unfair termination provisions will be
Fe the eligibility requirements to access that jurisdiction”.

In what circumstances will ‘unfair termination’ occur?*
A person has been unfairly terminated if:
• the person was performing work in the road transport industry; and
• the person has been terminated;
• the termination was unfair; and
• the termination was not consistent with the Termination Code.
When determining whether the termination was unfair, the FWC must consider whether there was a valid reason for the termination, whether relevant processes (as set out in the Termination Code) have been followed, and any other relevant matters.
The Termination Code (yet to be published) is a legislative instrument that the minister must make dealing with what may constitute a valid reason for termination, rights of responses, internal processes and communication in relation to any termination.
The Department of Employment and Workplace Relations has undertaken consultation with respect to what should be in the Code, but
As set out in the new regulations, serious misconduct includes:
• wilful or deliberate conduct which is inconsistent with the services contract;
• conduct that causes serious risk to:
• the health or safety of a person; or
• the reputation, viability or profitability of the relevant road transport business;
• engaging in theft, fraud, assault or sexual harassment in the course of performing work;
• being intoxicated in the course of performing work;
• refusing to carry out lawful and reasonable instruction that is consistent with the contract.
What remedies are available for unfair termination?
The two remedies for unfair termination are reinstatement (a new contract is entered into on the same or similar terms) or payment of compensation. Reinstatement is the preferred remedy, and compensation may only be awarded

if reinstatement would be inappropriate. Reinstatement of the contract must be on the same terms as the services contract at the time of termination, or with variations that the FWC considers appropriate. In addition to reinstatement, the FWC may make an order to restore any pay lost, or likely to have been lost, because of the termination. If compensation, rather than reinstatement, is ordered, any compensation will be determined having regard to a variety of factors, including the
effect any order may have on the viability of the principal contractor, the income the person would have received but for the termination and any income the person made between the termination and the making of any FWC compensation order.
Any compensation is capped at the amount the person received, or was entitled to receive, during the six-month period before the termination.
*Q&A information above was supplied by NatRoad. For more visit natroad.com.au
FOOD delivery riders and AmazonFlex parcel couriers are the first groups to exercise new rights to apply for enforceable standards for gig workers under the Fair Work Commission’s new road transport division.
The first-ever applications include a safety net on pay to ensure workers can recover their costs, earn a living wage, and be compensated for the intermittent, uncertain nature of their work.
Other entitlements in the applications made by the Transport Workers’ Union include company-funded superannuation and safety training, as well as consultation and representation rights.
From August 26, ground-breaking new laws have taken effect with a dedicated Expert Panel of the Fair Work Commission (FWC) tasked with setting standards
to make road transport “safe, sustainable and viable.”
Gig workers and owner-driver couriers and truckies now have access to the FWC for the first time.
A further application from truck drivers under the laws will call for fair payment terms in transport supply chains, preventing wealthy retailers, manufacturers and oil companies from passing financial risk onto operators and owner drivers on razor-thin margins.
The TWU’s applications take issue with what the union describes as the ‘Amazon Effect’, union-speak for transport supply chains squeezed by wealthy retailers at the top, while unregulated gig competition has ripped away standards from the bottom.
Decades of evidence has shown the link between low pay and poor safety outcomes in Australia’s deadliest indus-
try, the union said.
“With these applications, we are redesigning the deadly transport industry, and not a day too soon,” said TWU national secretary Michael Kaine.
“Gig workers have been killed, maimed and exploited with no access to rights and protections until now. In the broader transport industry, almost 500 workers have died and more than 3,500 businesses have collapsed over the last decade alone.
“Making these applications during the first week of this ground-breaking legislation is a watershed moment for Australia’s 500,000-plus transport workers, their families and the entire community.”
Kaine said no household is untouched by the efforts of transport workers.
“We share the roads with trucks, courier vans and food delivery bikes every day. With
the boom of online retail and food delivery, consumers have come to expect rapid deliveries to our doors, but also expect that drivers are paid properly and work under safe conditions. From today, at last, that reality is coming into focus.
“Over time, these standards can be built up and expanded out until we have eradicated the Amazon Effect that has brought deadly exploitation and unsustainable competition to the transport industry.”
Under the new legislation, the applications will be referred to a Road Transport Advisory Group (RTAG) of registered organisations, which will coordinate subcommittee consultation with relevant parties in order to inform the expert panel on standards. RTAG member Peter Anderson, the ARTIO national secretary and VTA CEO, said the new laws will be a huge win for the industry.


















While the 780 can claim bragging rights as the most powerful engine,
torque that really gives the new Volvo the grunt to pull like
BY GEOFF MIDDLETON
AS we reported recently, Vol vo has announced its new D17 engine with 780hp and 3800Nm of torque. It is now the most powerful produc tion engine available in the country.
The new 780 is the new king of power and torque, taking over from the Scania 770 V8 as the most powerful production truck on the road.
The 17-litre D17 engine has a range of horsepower rat ings from 600 to a whopping 780hp, and we got our hands on one towing three load ed trailers out of Geraldton, WA.
The 17-litre, Euro 6 power plant shares the same basic architecture as the 16-litre six-cylinder engine it replaces with the extra capacity result ing from an increase in cylin der bore.
In pursuit of efficiency and cleaner operation, the en gine also features a new fuel injection system, low-fric tion cylinder liners as well as wave-top pistons designed to optimise combustion.
While the 780 can claim bragging rights as the most powerful engine, it’s the torque that really gives the new Volvo the grunt to pull like never before.

Our test truck was a very WA-specific spec with load-sharing twin-steer frontend in an 8x4 configuration.
We were towing an AB-triple ‘grain train’ trailer set which is a typical setup for grain work in the west.
The Volvo prime mover was rated at 150 tonnes and our weighbridge docket read 106.8 tonnes, so this was going to be a real-world test for the new 780.
The 150-tonne rated Volvos have a single reduction rear end with hypoid gears whereas the trucks rated over 150 tonnes a have hub reduction rear-end with conical spiral-cut gears.
Our planned drive route would take us east out of Geraldton through Mullewa and Yalgoo to Mount Magnet and return. A distance of just under 700 kilometres
well-specced and comfortable place to work.
What we really wanted to know was how the new engine performed under this rather arduous test.
We set off early from Geraldton to give us plenty of time to get to Mount Magnet for lunch with a couple of stops along the way to get a few photos and stretch the legs.
From the initial take-off, the massive torque of the D17 is a standout. Looking at the torque curve on a graph, it’s evident that the maximum of 3800Nm is achieved between 1000 and 1200rpm, but even at 1600rpm, as it starts to drop off, it’s still producing 3400Nm.
It’s a huge amount of torque and translates to a truck that can haul the three trailers with ridiculous ease. I made the comment on the drive that it didn’t feel like I was driving a triple, it felt more like a B-double with about 40 or 50 tonnes, not 107.
drive. I found it liked to sit on about 1250rpm and just purred along.
it’s the
never before.

common on this road, it would hang on to top gear in the 12-speed I-Shift auto down to about 1100rpm then smoothly shift into 11th if necessary, hardly noticing the hills.
The I-Shift auto is a new generation which has been beefed up to take the extra power and torque of the D17 780hp engine. The new generation is across the board for the D17 with subtle changes for the different horsepower ranges.
What Volvo has done with this new engine is something that they call ‘downspeeding’ which is where the team is trying to get the engines to rev lower which results in bet-


ter fuel economy. One of the ways they are doing this is by running taller diff ratios.












LS001TRP $1,699
Suits T404, T404S, T604, T650, T350, T350A, T401, K104, K104B, K108, T359, T359A & K200
LS002TRP $1,850
Suits T408, T608, T658, T403, T408EX, T409, T609, T659, T408SAR, T409, T610, T409SAR, T360, T360A & T410
STORE FOR COMPLETE RANGE










From page 14
There is one big hill on the return trip which the big Volvo handled with ease, getting down to about eighth. On the flat sections, we were cruising along at about 90-100km/h with no trouble at all.

At one stage, we were stuck behind a big quad full of ore travelling at 70-80km/h but as soon as we came to an overtaking lane, we marched past effortlessly.
However, it’s not all about charging along and ripping up hills, there’s a downhill aspect to this truck as well. And while we didn’t have many serious descents to deal with, there were a couple of useful downhill runs.
stalk, or you can do as I did and slip the transmission back into manual mode and drag it back a couple of gears.
To back that up, the FH16 is fitted with an excellent electronic braking system (EBS) which includes ABS and electronic stability control (ESC). Driving the FH16 780 is an absolute pleasure. It’s easy to get comfortable in the driver’s suspension seat with heaps of adjustment, and the steering column is adjustable for rake and reach.
All the controls are easy to get at and well laid out. The stubby transmission shifter sits neatly on the left of the driver and falls easily to hand for those manual downshifts,
view of what’s happening behind.
The Globetrotter cab is a roomy space with plenty of storage for all your gear and a mattress that is 213cm long and nice and wide for good night’s sleep.
But if want more room, you could opt for the XXL cab. The XXL cab now has one of the biggest beds in the business – 130mm longer and 250mm wider than in a regular Volvo FH, providing plenty of space to stretch out.
Of course, as with all Volvo trucks, safety is a big deal and the FH16 comes with full suite of safety features.
Standard fare are things such as adaptive cruise control,


versation in the cab or hear the radio with only a slight rumble of the big six under the cab.
Our trip took us about 10 hours which included a lunch stop at the Swagman Roadhouse in Mount Magnet (excellent burgers if you’re ever in the area) and I felt quite refreshed when I stepped out of the truck.
IT’S RARE THAT I GET OUT OF A TRUCK WITHOUT A FEW GRIPES, BUT THIS TRUCK IS ONE OF THEM. IT’S A LOVELY TRUCK TO DRIVE, IT’S POWERFUL, QUIET AND REALLY WELLMANNERED.”
At the end of our near-700-kilometre trip we were showing fuel usage of 87.6 litres/100kms or It’s a lovely truck to drive, it’s powerful, quiet and real-
It went about its business with a minimum of fuss and
It’s one of those trucks that I’d use as a benchmark from
So, if you’re in the market for a truck to do some serious heavy lifting, see if you can track down a Volvo FH16 780 for a test drive. It will






















BY GRAHAM HARSANT
THIS year saw 54 legends of the transport industry inducted into the Shell Rimula Transport Wall of Fame in Alice Springs.
Their stories will hang in perpetuity at the National Road Transport Museum alongside the hundreds of other trucking greats.
Amongst the worthy inductees on August 24 was one Mario Giacci.
Migrating from Italy to Australia at the age of 15, Mario’s story is not just a tale of business success, but of the migrant making a profound impact in a new land through his resilience and innovation.
In the 1950s, Mario and his brother Tony established A&M Giacci. What began with one truck would mark the beginning of the legacy spanning over five decades.
The company evolved to Giacci Bros, then to Giacci Group, before being sold in 2012. Mario’s ability to complete jobs on time, with minimal fuss, earned him reputation for reliability that his children wore keen to emulate in their business, MGM Limestone and, later, MGM Bulk.
Based in Bunbury, Western Australia the business has operations and depots scattered throughout Western Australia, employing around 550 people – many of them FIFO workers.
Possibly in that FIFO spirit, grandson, James, who is the company’s Marketing Manager, flew 66 family, friends and employees on a chartered jet to witness Mario’s induction into the Hall of Fame.
“We are a family business,” said James. “We have been in the transport industry for 65 years now and these are all people who have played a vital role in our company. Bringing all these people along for the ride as well is the least we could do. These are long-standing relationships with a lot of the people over here so it’s important to have
them here celebrating with us.”
“They all helped me to get this award,” added Mario, talking about his people.
“Without them I would be nothing. It is an honour.”
Today at 85, Mario still travels up to Port Hedland and Geraldton every fortnight to check in on his operations. He reckons this makes him the country’s oldest FIFO worker.
He also gets up the boys if the trucks are dirty.
The company has just taken delivery of its 200th Kenworth, but Mario’s first truck was a Mack, which was on display at the induction ceremony.
Encyclopaedic knowledge rewarded
Sue Wright’s face was one bewildered surprise when her name was called to receive her Plaque commemorating her induction into the Wall of Fame.
Sue has dedicated over 50 years to the transport industry and is known as one of the best parts interpreters in Australia. She may not have driven a truck but she is responsible for having thousands of them on the road.
Her attitude towards triple checking that the right parts were being sent, might have frustrated her colleagues but made her an asset to every business she was part of.
She was working for herself when she had her daughter, Yvette. She gave birth on a Saturday and was out deliver ing to her customers the next Monday with baby in tow, such was her dedication to her job.
In 2010 she was recruited to run the spare parts division of Mick Murray Welding in Darwin, and later to open and run the Alice Springs business.
“I couldn’t believe that she actually wanted to work for us,” said Mick.
“We have had a wonderful relationship, never had a cross word with me or with a cus tomer – and that’s worth its
weight in gold alone.
“Ask her about a part for a 1991 Ford Louisville and she will reel off the number without glancing at the computer. I’m surprised she didn’t call her kids AV6014 or B6013 instead of names.
“I’m constantly in disbelief that not only did I secure an employee of Sue’s calibre, but that I’ve managed to keep her on board for the past 10 years. She has an absolutely brilliant knowledge of anything relating to the transport industry. She is an encyclopaedia.
“I bought her a St Patrick medallion, a Guardian Angel medallion and another Saint medallion to look after her, because she is always talking about the saints that find you things. Our Sue though, is the Patron Saint of Spare Parts.
“She is talking about retirement to Adelaide. I’m going to tie her to her desk!”
Mick flew Sue’s daughter, son, sister and a couple of friends to Alice Springs to witness her induction.
Laurie has last laugh Lawrence Williams was told by a teacher that he’d never amount to anything looking out a window.


ing tow trucks in Redcliffe. D-Series Ford, He went on to start Laurie Williams Car Carrying Company.
When he sold his business in 2000, Laurie retired for aing a role providing dealer der his new company, North QLD Truck & Machinery


of the famous Bullet Burn out Truck (previously the Bandag Bullet), which is held the Guinness World Record for the fastest diesel-powered truck since 2005.
orating the side. He couldn’t have imagined that one day he would have 200 staff and more than 100 trucks and 300 trailers that proudly carried his name. Richie started tracking in 1969 and, within two years he





Transport. He secured a con tract for coal, gravel, grain and ammonium nitrate.
His willingness to take a risk set Beaumont Transport apart. He was amongst the first to run bulk B-doubles and use BAB quads in southeast Queensland.
After 45 years in business, Richie sold in 2014 and today has reacquired a couple of his oldest trucks for restoration.
Community-minded driver has great run Ronald ‘Jacko’ Jackson was born in 1939 in Arncliffe, New South Wales.
rld War II. In 1953, Jacko got pulled over by the police for not indicating. Aged only 14, his hands were too small to be indicators!
For 10 years, from 1965 to 1975, Jacko was driving around Sydney, delivering television tubes in a Daihatsu Delta.
He then moved to Edgell, driving freezer trucks, he went on to drive school buses, coaches and, in 1999, finished up driving a 15-seater bus as a volunteer for Centrecare.
Jacko has very much en-
He remembers a time when he and his best mate Barry, after pulling an all-nighter in the pub the night prior, turned up in suits to load sheep.
From US city traffic to remote mining sites
Trevor Perry started offsiding for a local maintenance contractor in Woomera in 1986. The business had two concrete trucks that Trevor learned how to operate. Soon enough he was driving the smaller trucks himself.
Trevor, looking for a change, secured a role with CalArk in the US. He cov


to R hodes contracting, now Exact Contracting, where he would spend the next 17 years.
As a heavy haulage driver Trevor’s role involves the mobilisation and demobilisation of machinery to mine sites and road construction
By 1969, Bill was driving full-time for local carrier to Adelaide.
On one of his ‘routine’ trips, he popped the front wheel brake cylinder and lost all breaking mechanisms. This made him the first per


son to use the safety ramp in e Adelaide Hills. Bill and wife, Kate, purchased Stawell Haulage – now Stawell
Three prime movers, five trailers and a forklift formed the fleet for their new busi-
They picked up a great team of drivers, some of whom are still with them today.
With 57 years in transport under his belt, Bill has no plans to retire just yet.
Continued on page 20






BY GRAHAM HARSANT
AN industry icon himself, Jim Hurley was at the Hall of Fame in Alice Springs last month to present the Industry Icon Awards for 2024.
Industry Icon: Gordon Martin
Gordon Martin commenced business in Singleton in 1958 with one truck, carting pigs and calves to Homebush abattoirs in Sydney, and a lifelong bond with the industry was formed.
Hard work and a keen eye for business enabled Gordon to capitalise on the many opportunities that came his way. He was soon carting fertiliser in bulk from Newcastle into the Scone area, later taking cattle from the saleyards at Maitland and Singleton to the abattoirs at Riverstone in Sydney.
Gordon and his wife, Denise (dec’d) focused on bulk haulage, transporting coal from Hunter Valley to Newcastle, as well to the local rail hits to be loaded onto trains for the journey east. The bulk fleet now outnumbered livestock division.
Gordon would go on to sell much of the bulk haulage business and the depot at Ravensworth, movies livestock division to Scone. The business retained six bulk haulage trucks which are contracted for the cartage of dangerous goods.
There were times in those early days when Gordon must have questioned where he was heading but, in typical Martin fashion, no job was too big or too small and each received the same amount of attention. Today the livestock division runs 68 trucks comprising B-doubles and multiple combinations of trailers, predominantly across the eastern
From page 19
More time on dirt roads than bitumen
Lance Thomsen would hear a truck start and he had to be in it.
states.
Gordon has been a great contributor to state associa tions in New South Wales and Queensland. A director at the ATA from 2014 to 2016, he was awarded Life Member ship of the ALRTA in 2018.
Duty-bound to improve the industry within which he op erated, he led the charge in the early 90s for on-road access for B-doubles and the dual tax rebate.
Gordon has empowered his staff to lobby hard for the in troduction of ‘ramp standards’ to support driver safety and to push for better outcomes in environmental space regard ing effluent spillage and bio security risks.
Turning 86, 66 years in business this year, Gordon is known as a kind man who is committed to looking after the people who make his business so successful.

Industry Icon: Sam Sali (dec’d)
Sam Sali was born in 1937 in Voskop, Albania. He was just three months old when his family settled in Shepparton, Victoria, having been told the town was reminiscent of their homeland.
Sam completed a Motor Mechanic apprenticeship beginning in 1953 with Favalloro Motors. Although an apprentice, he was treated with respect and this helps set the standard for how Sam would go on to treat his own employees.
In 1956 S.Sali & Sons was born when Sam and his brother, Adam bought their first truck to carry fruit to the Melbourne market. In 1958 the brothers took delivery of their Diamond T (still in the family) and semitrailer truck, the business growing to three trucks by 1961. Sam spent many years behind the wheel
as well as performing or servicing and maintenance. In the 70s he began learning the managerial side of the business, working alongside his brother.
Sam was a foundation member of several leading road transport organisations including the National Transport Federation (1986).
When the NTF merged with the Long-Distance Road Transport Association to form NatRoad in 1994, Sam served as a director until 2001.
In this role he worked to restructure the Road Transport (Long Distance Operations) Award and introduce enterprise bargaining to the industry.
Sam was committed to improving the image and furthering the professionalism of the road transport industry, emphasising ethical operational methods.
To this end, S. Sali & Sons


never accepted clients who demanded unreasonable delivery times, to this day remaining dedicated to the safety and welfare of the companies drivers.
In 2003 Sam was awarded the ATA’s National Award for Outstanding Contribution to the Transport Industry.
A proud family man, Sam’s marriage to Nina (Dec.) produced four children. Conscious of community he served the Shepparton Albanian Muslim Society for over 40 years and the Rotary Club of Shepparton for over 50, never missing a meeting.
Sam passed away surrounded by family on January 7, 2024, eight days shy of his 87th birthday. Continuously giving so much and asking for little in return, he is quoted as saying, “You cannot look with envy on what someone else has.
You must understand the
effort and sacrifice that went into it. Nothing is achieved if you don’t put your effort in.”
Sam Sali’s award was accepted by his daughter, Linda.
History Maker Award:
Kurt Johannsen (dec’d)
Kurt Johannsen was born in 1915 at Deep Well, in the Northern Territory. Kurt exemplified progressive innovation and was truly a pioneer to whom the transport industry owes its thanks.
His ingenuity was clear as early as 11 years old. Having just acquired his driving license, he would hook his model trucks together with two, three and sometimes four trailers with wire towbars around bent nails.
By 15, Kurt was driving his own truck, carting general freight. His work in cattle transport commenced after the war and Kurt realised that there was plenty of room for
improvement in the carting of livestock. An inventor first and foremost, he already had plans in mind for building a road train with self-tracking trailers. At an army disposal sale, he purchased 23 Bren-gun carrier recovery trailers. After designing a rough sketch on paper, got to work. The self-tracking trailers were 13 m long and weighed eight tons. They were specifically designed to follow the prime mover tracks perfectly, were ideal for transporting cattle on a narrow, winding and Sandy Bush tracks of the NT. With the trailers their completion, Kurt needed a prime mover which was powerful enough to haul three loaded trailers.
He’d purchased 10 heavy duty International rear axles and thought he’d make it 8-wheel drive, like the old A.E.C road train, but much longer and more powerful. General Motors refused to supply Kurt with a reasonably sized motor so he travelled to Darwin where he found a Diamond-T tank transporter. Through to friends and investors, he managed to raise enough to purchase a truck. It was then that ‘Bertha’, the first road train was born.
After retiring from mining and transporting operations in 1980, Kurt purchased a small hobby farm near Yankalilla, South Australia, passing away in 2002.
Beyond his own impressive service, Kurt believed strongly in honouring those who worked beside him in improving the industry and those who would continue this work. He was a founding member of the Road Transport Historical Society, donating $500 to kickstart the National Road Transport Museum we enjoy today. Kurt’s award was accepted by his son, Dominic.
Mark
Wayne
Lance has carted everything from fridge vans and general freight, to oversized work and tippers.
In 2001 plants spent multi-
This, before he could walk. His passion showed no signs of settling in his teenage years and he left school at 14 to work in the industry.
ple days at Uluru unloading and reloading a Chinook helicopter that was sent from Townsville with emergencies supplies to send to the flooded communities.
There is not a desert Lance hasn’t worked in, declaring
he has spent more of his life on remote dirt roads than he has on bitumen.
Now in his 19th year with G&S Transport, Lance may well be in the running for the title of the most time spent driving the Tanami Road.
Mark Rucioch
Shane Ruhl (dec’d)
Peter Sands (dec’d)
Steven Smith (dec’d)
James Souvlis (dec’d)
Michael Spears
Dennis Steenholdt
Lance Thomsen
Ray Wellman
Robert Whitehead (dec’d)
Lawrence Williams
Sue Wright
Mario Giacci
Industry Icon: Gordon Martin
Industry Icon: Sam Sali (dec’d)
History Maker: Kurt Johannsen (dec’d)
These men and women, along with all the other inductees, are worthy of recognition by the transport in-
Springs Road
that they
take their place on the walls with those that have


At Isuzu, we’ve always taken great care of our customers.
We’re Australia’s number one truck… an honour we’ve held for over three decades.
That means more businesses put their trust in us than any other truck brand.
We understand that reputations are riding on us and that’s why Isuzu Care is more than just an aftersales service package.
It’s part of our DNA.
From day one, we support customers and demonstrate that reliability is everything. We pride ourselves on being proactive and always going the extra mile.
And as we look to new frontiers, we’re finding new ways to help our customers exceed their goals.
Isuzu Care is what sets us apart. Always has, always will.

BY GRAHAM HARSANT
AS this article is published, the National Road Transport Historical Society - after 4.5 years of statutory management – will revert to being controlled by an independent board, with experienced trucking industry businessman, Frank Bilato as chairman. Big Rigs sat down with CEO
Nick Prus in Alice Springts to find out what the future holds.
“To say that we are looking forward to the future is an understatement,” said Nick. “It is now in our own hands. Some 70 per cent of our buildings are non-compliant and with the ageing infrastructure, we needed government support.
“The NT gave us a $3.5 million development grant which will not only build more sheds

and fix old ones, but also develop our 10-year strategic plan, so we know that the Hall is going to be here for generations to come.
“We also received a $100,000 operational grant, plus $216,000 to rebuild the ablution blocks in our camping ground for volunteers. I really want to thank the NT Government for realising how important this place is, not just to Alice Springs and the Northern Territory, but to the whole country.”
Nick said part of part of the development plan is to create and continue with the Hall of Fame as a crucial part of their entity.
“We are here to honour people behind the wheel, people that built this country, so that in fact will just grow better.”
A new entrance to the hall to replace the current building is in the planning stages, with Nick believing that extra government funding could be available if needed.
As well as the trucking history, there are other plans afoot to draw people to the Hall of Fame. There is currently an RSL museum on the grounds, which that association wants to expand.
“They want to build their own home here; to build a hall which would reflect a 1940s army camp with Nissen huts and so forth.
“I know they have approached the federal govern-


gifted an Airbus A380 double-decker plane which is currently sitting at Alice Springs airport.
“We are working with a couple of companies to get a quote to bring here. It is 9 km in a straight line but there are obviously logistical problems,” said Nick, whilst pointing at a map on his office wall, showing its proposed location.
“I know it’s not road transport, but would be an extra drawcard. I believe there are only two of those planes available to the public and they are both in Europe.
So, this would be the only one in the southern hemisphere that you can get on. It is intact, minus its engines. How many of us have sat in first-class on an A380? Hopefully Qantas would come to the party and paint it in their colours.”
Next year will be the 30th anniversary of The Hall and Nick is thinking big.
“The street parade is definitely going to happen and we have confirmation of truck drag racing plus a whole lot more.
“We are looking at a whole week of celebration and hope to attract around 10,000 people next year, with anywhere from 1000-1500 people at the dinner, and more than double


the number of Inductees.
“We will make it as big as possible. If anyone could spend a couple of weeks here to volunteer we would be beyond grateful.
“Also, if anyone has any ideas – how better we could honour people in the trucking industry please contact us.
proud of the company’s association.
Send us an email at admin@ rths.com.au.”
So, after much hard work by Nick Prus, his team and many others who love this industry, the future of the Hall of Fame is assured.
Now we just have to wait to see if the first-class bar will be open on that Airbus A380.

lot for our business.
said Nick.
“We are obviously critical suppliers into the transport industry and this is such a terrific honour for the people being inducted, as well as their families and friends, after a lifetime committed to the in-
“I flew up and sat next to a bloke by the name of Brendan, and his son who was about eight years old. Brendan’s dad was getting inducted, as was his grandfather some years before.
“What that tells you is how much it means; it’s generational for people. They’re really proud to be part of it, regarding it as a huge honour. One of the main reasons for
As with past years Nick bought some of his team up to experience the inductions.
“It is a really hard event to explain. You have to be here to experience the weekend and what it means to so many. You can talk to people about it back at the office, but being here and seeing it really brings it to life.
“Our sales teams deal with transport companies all around Australia and this is a great chance for us to get
a critical part of keeping the transport industry moving along, so it is a really nice, natural association for us.
It’s brilliant to see everybody getting inducted and it’s also great to have dinner with everyone afterwards.”
Nick said the history of Shell in Australia is so long that people always have stories about a Shell roadhouse experience back in the day.
“Every year I’ve been here,
with some of the things that occurred back then, in this day and age.”
Could there possibly be another sponsorship opportunity for Shell, as the Hall of Fame has been given an Airbus A380? (Shell’s parent company, Viva Energy are well-known for supplying aviation fuel.)
“I think they pulled the engines out of it so our product’s not going to help them a lot in that regard,” laughed Nick.


BY DANIELLE GULLACI
AFTER being offered the job of her dreams, experienced MC truckie Corrina Riley didn’t hesitate to make the move some 600 kilometres away to outback Queensland.
She and her 14-year-old son Jack relocated from Brisbane to the small town of Moura in central Queensland in late July, starting a new role with Qube on August 6.
From behind the wheel of a Kenworth C509, pulling a BAB quad, Corrina transports coal from the Baralaba mine site to a train load-out facility – pulling up to 111 tonnes of the product.
It’s approximately a 2.5 hour round trip.
Though she’s driven everything up to triples, this is Corrina’s first time in a quad – something that has been on the bucket list for quite some time.
“For me, this is like a dream job. When I first started driving triples years ago, I’d drive past the quads and would always say I wanted to drive them one day – and here I am,” said Corrina.
the right move for her.
“It really was hard to leave but once my landlord put the house we were living in for the last seven years on the market, I said, that’s it, I’m doing this – and it’s been the best move I’ve ever made,” Corrina said.
“Moura is quite a small town, there’s only about 2000 people here I believe. But Jack and I came from property before moving to Brisbane.
“Jack loves it here too. He wants to train to become a diesel mechanic and has some work lined up.”
It’s also Corrina’s first time in a C509. “I love it, it is the best to drive. The truck drives beautifully.”
And as for the BAB quad, Corrina added, “They ride and track like a double, which is really good. It’s just super long and heavy. It’s 50 metres long, so when you look back, it’s like a snake following behind you.”
The new role is on a 10 days on/10 days off roster, which has been a really great fit for Corrina, who also works as a driver trainer with McCullough Training & Transport Services when she’s not
BEHIND THE WHEEL WITH ALL THOSE TRAILERS BEHIND YOU – IT’S PHENOMENAL. I JUST FEEL LIKE I’M ON TOP OF THE WORLD.”
CORRINA RILEY
and more experienced female operators joining the company’s Baralaba mine operation.
“We’ve had quite a few female operators in the past and they’ve all been great workers. With Corrina here, we have three ladies working with us now, who are all multi combination operators,” he explained.
“It’s really good to see that women are coming in and showing some of the guys that they can do the same job, sometimes even better. If anyone is interested in looking into the industry, don’t tell yourself you can’t do it, because these women are proof that you can.”
Ken says that he sees a lot of applications come through for these sorts of roles at Qube, but given the nature of the vantageous, but we like to see


at minimum road train or AB triple work. Although we’ve had some operators come in with only B-double experience and they’ve proved to be really good operators.”
The business also places all of its new recruits in on-thejob training. “We have a certain amount of days where
trained up on the run. Then they are signed off once they are ready,” explained Ken.
Corrina added, “I did three days of training and then got signed off at the end of the fourth day so I could go out on my own.
She continued, “It’s the best job. Behind the wheel with all
phenomenal. I just feel like I’m on top of the world.
“Everyone there is so nice too. I’ve found everyone to be so helpful and nice. To be doing what I’m doing around good people in a good atmosphere, has been great.
“For anyone looking to come up this way, it’s so

BY DANIELLE GULLACI
FOLLOWING a lifetime spent in the transport industry, with numerous awards under her belt, Roslyn Anderson has finally taken the plunge and secured her truck licence. Roslyn has worked in numerous roles over the years, including currently serving as Women in Trucking Australia’s (WiTA) treasurer and a current board director. She was also named the ATA National Trucking Industry Woman of the Year in 2020; and the Road Freight NSW Woman of the Year in 2018.
As the daughter of a truck driver, Roslyn has quite literally been around trucks her
whole life. But despite her many years in the industry, she says the fact she didn’t have a truck licence herself had been bugging her for a long time.
So Roslyn decided to do something about it and sat her HR licence recently without telling anyone – until she passed.
“I have had the idea of getting a truck licence as a New Year’s resolution for the last three years in a row. It all just seemed a bit hard to do,” she confessed.
“I was the only person on the board of WiTA who did not have a truck licence! I didn’t discuss my plans with anybody because I thought I
would fail. I thought I’d only tell them when I passed.
“I’m glad I finally got my licence. I honestly thought it would be so difficult, so it was more than a relief to pass. It was an absolute joy to be able to achieve something that to me is such a great thing.”
Roslyn says her driving instructor helped allay her fears, instead filling her with greater confidence.
“The instructor told me that I already know how to drive, I know all the road rules so all I had to understand was the size of the truck and the difference there is with sharing a narrow road, turning a corner, and parking the truck. He was absolutely right. I spent a
few hours driving around and then went straight on to the driving test,” she explained.
“I thought everything would be so difficult but it wasn’t really. I would encourage any woman to give it a go. After the test I got back in my car and at the first intersection I thought, I can’t see as much as I can in the truck!”
Now that Roslyn has her HR licence under her belt, Big Rigs asked if she plans to eventually go for her HC.
“The other girls on the board will now drive me crazy because they drive really big trucks. Give me a few more years of procrastination and I will probably upgrade to HC.”


At Capricorn, we’ve done the hard work for you. With one consolidated trading account across thousands of suppliers, we’ve got all the parts and services you need to run a successful heavy vehicle business. It takes the hassle out of managing multiple payments – plus you’ll earn Capricorn Rewards Points for every dollar you spend, putting cash in your back

Find out more about the benefits of belonging to Australia’s largest coop for automotive.
One trade account Quick access to parts & services
Generous Rewards Program No joining fee
The McIver family enjoys the best of both worlds with the hard-working ‘Dark and Stormy’, their 30-year-old 4964F, towing a converted horse trailer

BY DAVID VILE
FOR a lot of people, getting ‘off grid’ and away from it all involves putting some dollars down on a four-wheel drive with a caravan or camper trailer swinging off the back of it.
But in the case of Brendan McIver, it is just a simple matter of swapping the trailer behind his 1994 Western Star and switching from work to relaxation mode.
Recently Brendan and his 13-year-old son Ben had
made the trip to Winton in northeast Victoria to the August round of the Australian Super Truck Nationals, with the Western Star hauling the trailer, which has been fully set up as a self-sufficient camper unit.
Both the Western Star and trailer have been a part of the McIver family, which is based at Willow Grove in Victoria for over two decades.
The 30-year-old truck still works every week, while the trailer, which had initially been used as a horse trans-
porter, had recently undergone a three-year refurbishment and overhaul.
Nicknamed ‘Dark and Stormy’ by its original owner who ran it east-west across Australia, the Western Star 4964F, with a trusty Detroit Series 60 under the bonnet has been a faithful servant.
“I bought it when it was four years old from Peter Ball in Gatton and have had it since then,” Brendan explained.
“He used to cart bananas out of Tully across to Perth with it. Back then I was doing interstate and had a W-Model Kenworth that was costing me an absolute fortune, so I bought this.”
In the years following, Brendan ran the truck pretty much all over Australia on interstate, clocking around four million kilometres in that time, and today still puts in the hours each week.
“It still works full time; most people don’t believe that it’s a 30-year-old truck. Now I just run a side-loader with containers in and out of the wharf and that sort of thing.
“We do mostly country work with it and occasionally run interstate if people pay the right money.”
Brendan purchased the trailer at around the same time as the Western Star from multiple Caulfield Cup and Group-1 race winning horse trainer Ross McDonald.
“He used it to move his racehorses around and just wanted it to go away with our horses for polocrosse.
“I stopped playing around six years ago when I broke my leg so that was the end of that. It had already been fitted out up the front so over the last three years we have

just been refurbishing it right through.”
Today, the trailer is geared up from top to bottom, from the solar panels on the roof running through to an inverter, along with the gas hot water unit and full kitchen/ dining and sleeping areas, along with a pull-out awning off the side of the trailer.
“Wherever we want to go we just want to be self-sufficient and off we go with all the mod-cons from home. With the solar on the roof and the inverter I can turn everything on at once like the air conditioning, kettle and so on and not have any issues,” Brendan said.
Down the back of the trailer, the rails for tethering the horses inside are still attached but only one steed goes for a ride today - a Suzuki Jimny four-wheel drive.
“We use the Suzuki as our little run-about. Obviously if you go away, you can set yourself up and the trailer as a base and jump in that to go where you need to go.
“It just fits in snug with not much clearance each sidefor now I just open the rear door and stagger out the back - which I will have to do until Ben gets the driving duties.”
With family friends racing in the Supertrucks at Winton over the weekend, Brendan and Ben had headed up the Hume to give the trailer its first workout since the overhaul.
“It was just magic on the road; you wouldn’t even know it’s there. Basically, it’s
out, so I reckon we have it about 98 per cent right,” he said.
While still out and about earning a dollar with his truck, Brendan has a few ideas of where the big Star might head once it is again hooked up for some recreational travelling.
“We might look at going up to Alice Springs next year and then head across and check out the Winton Truck Museum and things like that.
“With this all set up now

BIGGER isn’t necessarily better, according to Macway Logistics owner Shane Martin.
The hanging meat transport specialist has a unique perspective thanks to his large 16-litre Freightliner Cascadia 126 and its ‘little brother,’ the 13-litre 116 version.
“This is definitely my favourite,” says Shane, touching the bonnet of the smaller 116.
“It’s bloody awesome. It just goes hard, it’s great on fuel.”
The Macway 116 has a 36inch cab, compared to the cavernous 60-inch bunk of his 126, but that’s enough for Shane.
“It’s the smaller cab, but that’s still more than enough room to stand up and get changed and there’s room for the fridge, microwave and TV too,” he says.
Macway runs pork, as hanging meat, up the east coast out of Melbourne and Murray Bridge for Wilmeat Cut Meat and AusPork.
Both companies value the fact that Shane operates modern equipment that looks
great and is safe and reliable.
“These Cascadias have all the safety features you can get and they are all built in, which is good for my drivers and everyone else,” Shane says.
He bought the first 126 Cascadia from Daimler Trucks Adelaide, a sharply-dressed show truck, in the midst of Covid restrictions, which was one of the reasons he went for the colossal 60-inch cab.
“There was all the scaremongering, and I thought it would be good to have somewhere I could sit and not feel boxedin and it has the benefit of the fridge in the back and the microwave and everything,” he says.
He bought a Mercedes-Benz Actros and was thrilled with it but had to sell it after work dried up.
As luck would have it, almost as soon as Shane sold the Actros, he won another contract and needed another truck.
Shane was okay though, because he used Daimler Truck Financial Services to pay for
the trucks and was able to get a Guaranteed Buy Back price, which made it all quite sim ple.
“So many trucks, the value goes through the floor and you end up doing your arse on it, but that buy-back thing gives you that peace of mind,” he says.
A few months later, with a new contract, Shane was able to buy a new truck and chose the Cascadia 116.
Asked what he thought about the Cascadia, Shane says the fuel economy is “awe some”, but feels its comfort is its best attribute.
“You could spend 12 hours driving one of these and get out of it really fresh. I had an other truck [not a Freightlin er] and you’d be buggered at the end of the day.
“You worked just as hard as the truck did, but these are completely different.”
Shane says the comfort the trucks offer is important.
“To get a good driver, you have to have a good truck and a comfortable truck.”



Congratulations to our Pic of the Month winner John Cavenagh. A $500

SHELL Rimula has partnered with Big Rigs in a big way – so there are even more reasons to send in your best truck shots.
Each month, the Big Rigs team will choose a #PicOfTheMonth, with the lucky winner receiving a $500 Shell Coles Express Gift Card.
Keep an eye out for our regular posts on the Big Rigs National Road Transport Newspaper Facebook page, calling
for your best truck photos and add yours in the comments, or email them to kayla.walsh@ primecreative.com.au.
Don’t forget to include a brief note about the truck and where the photo was taken.
We’ll feature some of the best photos in each edition of Big Rigs Newspaper, with one win ner announced each month.
Keep those amazing tr coming!






When the going gets tough, truckies keep everyone going







Packed with all the creature comforts, this eye-catching Mack is deserving of the nickname ‘Backroads Motel’.
BY KAYLA WALSH
ANDREW James spends five nights a week on the road, carting supplement for cattle feed – so when he decided to buy his first brand-new truck, he needed to get it right.
Thankfully, he reckons he’s nailed it with his choice – a flash Mack Super-Liner that puts out 685hp running through a 13-speed auto.
The truck was the right pick for Andrew – or Jamesy as he’s
usually called, unless he’s in trouble – for several reasons.
“Somewhere in life, you need a new truck, and I’ve always liked Macks,” he said.
“In the end, I could get a Mack quicker than I could get a Kenworth, and the price was a bit cheaper.
“I also thought it had better added features, and I liked the service agreement – I pay a certain amount a month and that covers my service for the next five years, there are no
IT’S GOT EVERYTHING IN IT THAT YOU WOULD WANT – A STAND-UP FRIDGEFREEZER, A MICROWAVE AND A 60” SLEEPER BECAUSE I’M TALL” ANDREW JAMES
hidden costs.”


The truck is nicknamed ‘Backroads Motel’ because Jamesy practically lives in it, travelling through the backroads from Benalla, Victoria to various feedlots throughout southern Australia.
“I’m away from Sunday late afternoon until some time Friday,” he said.
“Because of this, I really needed the truck to be comfortable.”
Jamesy stands at 188cm (6ft 2), so having enough space in the cab to move around easily was a priority.
He also wanted some creature comforts to make life easier on the road.
“It’s got everything in it that you would want – a stand-up fridge-freezer, a microwave and a 60” sleeper because I’m tall,” he said.
“Because I have the room, I can take a week’s worth of food with me, which is handy.”
He also chose to customise the dash panel, which he wasn’t a fan of.
“I thought it was a bit plastic-y and bland, so Mack organised to replace the main fascia panel with a carbon fibre look,” he said. “It’s much better now.”
Other than that, Jamesy is pleased with the interior setup.
“The way it’s set up, it moulds around to your left,” he said.
“Everything’s at your fingertips and it’s very easy and ergonomic.
“It’s got a smart steering wheel so all your phone controls, your radio controls and cruise control are right there on the wheel, you’re not searching for buttons.”


ing for an automatic, saying it
“drives like a car” and practically idles at 100km/h.
“I’ll never go back to manual,” he added.
But where the Super-Liner really stands out is when it comes to road train work.
“We needed this one to be able to tow some big loads,” he said.
“It’s powerful, it’s got great handling, it’s got so many safety features, and the braking system is amazing.
“It’s got 30,000km on it already and every day I appreciate how good it is. I definitely made the right choice.”
The experienced truckie purchased the rig from CMV Truck and Bus in Wodonga and spent six months getting it ready to go.
With Bel Air Truck Spraypainting in Brisbane looking after the striking paintwork and The Bling Man taking charge of the chroming and other extras, Jamesy is delighted with the finished product.
“Everyone was amazing to deal with, offering different ideas in the build-up, which was really helpful,” he said.
“I’m very happy with how the truck turned out.”
Right after the Mack was finally finished in June, it made its maiden voyage to the Alexandra Truck Show, where it impressed the judges enough vto land its owner trophies for Best Under 12 Months and Runner-up Truck of the


“I didn’t go there to win any awards – I just wanted to get it to the show while it was clean and new!” Jamesy said.
“I knew it was going to be used for farm work so it wasn’t going to be clean for long - last night, for example, I was driving it through two inches of mud in Dubbo.
“I was totally amazed to win one award, let alone two.”
The successful operator has been involved in the transport industry his whole life, growing up with two uncles
who owned trucking compa nies and going on to set up his own business, Jamesy’s Transport.
The Mack will join the rest of his fleet, which consists of two Kenworths and a Freightliner Argosy.
The 60-year-old hopes the new addition will see him out until he retires, which he reckons will be about seven years.
He laughed: “If I’m still driving trucks after I’m 67, I reckon I’ll have to have a good hard look at myself.”








AUSTRALIA’S largest inte grated exhibition and confer ence for the logistics industry, MEGATRANS 2024 returns to the Melbourne Convention and Exhibition Centre on September 18-19.
The expo will showcase cutting-edge technologies and services for the supply chain, from vehicle telematics and fleet management software to
TRANS 2024 director Lauren Chartres said, “We are excited to welcome such a dynamic group of exhibitors to MEGATRANS 2024.
“This event is not just a platform for showcasing products and services but a hub for knowledge-sharing and networking among industry deci-


sion-makers.”
Visitors will be able to enjoy interactive displays, live demonstrations, and the opportunity to speak with experts in their respective fields.
MEGATRANS will also feature a conference, with

planning.
Over 100 exhibitors will be at the 2024 event, along with over 40 speakers.
MEGATRANS 2024 is a free event, however registration is essential.
In addition to the exhibition and conference, there will be a Mercury Awards Gala Din ner, with six awards being pre sented:
speakers from Toll Group, Deloitte, JLL and more, discussing a range of industry issues that are critical in shaping the future of the sustainable supply chain, including workplace diversity, an ethical supply chain and real estate
To register to attend MEG ATRANS 2024, please visit megatrans.com.au. During registration, tickets to the

Awards will be presented across six categories

THE weather is heating up, and so is the truck show calendar.
Clarendon Classic
Machinery Rally
September 21-22
Clarendon, NSW sydneyantiquemachineryclub. com
Held at the Hawkesbury Showgrounds on Racecourse Road in Clarendon over two days, this event offers something for everyone. Check out some classic rigs at the Kenworth Klassic Truck Show, hop on an old double decker bus to Richmond Station, or explore the displays of vintage machinery, including stationery engines, tractors, steam engines, models and more. Entry for the general public is from 9am to 4pm Saturday, and 8am to 3pm Sunday. Admission is $10 for adults and $5 for chil dren. Exhibitors enjoy free
admission, complimentary camping, a welcome BBQ on Friday night for a gold coin donation, and a two-course rally dinner on the Saturday evening.
Young Big Rigs Truck Show
September 22 Young, NSW youngshow.com.au
The Young Truck and Bike Show is back for its third year, with prime movers and rigids, cars and motorbikes all welcome. Prizes are up for grabs for the best-looking rigs. For more information and entry forms email youngshowsociety1@gmail.com or phone 0435953580.
Gold Coast Truck Show
September 29
Mudgeeraba Showgrounds, Worongary, QLD Facebook: Gold Coast Truck Show

combines with the GC Car & Bike Show to form three exhibitions in one at Mudgeeraba Showgrounds (exit 77 off the M1). All trucks enter Gate 3 at the back gate of the Showgrounds on Worongary Rd, Worongary from 6:30am Sunday September 29, 2024. Trophy presentations from 12.45pm centre stage.
Wauchope Yesteryear Truck & Machinery Show 2024
October 4-7
Wauchope Showground, NSW
Facebook: The Wauchope Yesteryear Truck and Machinery Club
Traditionally held in July, this year’s Wauchope Yesteryear Truck & Machinery Show has been moved to October – with plans for a bigger and better event. Vintage and modern trucks and tractors will be on display, with a tractor run on October 4 and a drive through Wauchope with a limited number of trucks and tractors on October 4 and 5. Unlike previous years, there will not be a Saturday night dinner, but the organising committee plan to have additional food outlets and a bar in operation to cater for the Saturday night meal.
Truckies Against Bullying: Truck, Car and Bike Show
October 5-6
Bendigo, Victoria Facebook: Truckies Against Bullying
Truckies Against Bullying is back with another great show this year, featuring plenty of trucks, cars and bikes to feast your eyes on. The fun at the Prince of Wales Show-
grounds kicks off with a convoy through Bendigo, while back at the showgrounds you can enjoy market and trade stalls, kids’ rides, food and drink, live music, and face painting. For more information, email truckiesagainstbullying@yahoo.com, call Andrew on 0484912382 or Sandy on 0499241605.
Boort Truck Show
October 12
Boort, Victoria Facebook: Boort Truck Show
Held in conjunction with the Boort A&P Society Show, the 2024 Boort Truck Show will feature a wide selection of trucks and fun for the whole family, with prizes across a range of categories. For more information phone Heath on 0428 382 725 or email heathsaunders@outlook.com.
Matty Hillcoat’s Truckies’ Day Out
October 12
from the Camp Quality Convoy Team. For more information phone 1300 662 2670 or email convoy@campquality. org.au.
Lights on the Hill
October 5-6 Gatton, Queensland lightsonthehill.com.au
Beaudesert Heritage Truck Show
Beaudesert Showground, Queensland October 19-20 heritagetruckassociation.com. au

Gympie, Queensland Facebook: Matty Hillcoat’s Truckies’ Day Out
Held at the Gympie Showgrounds, Matty Hillcoat’s Truckies’ Day Out kicks off at 9am and runs until late. Attendees can enjoy a truck show and parade, show ‘n’ shine display, timber sports, a tractor pull, a vintage machinery display, kids’ amusements, music and more. Entry is $25 for trucks (including one adult) and $20 per adult, with concession $15, kids $5, and kids under five going free. For more information, email khillcoat@riversgift.org.
Camp Quality Convoy
Perth October 13
Perth, WA campquality.org.au
Save the date for this event
Lights on the Hill is an opportunity for the transport industry to gather and remember truckies who have lost their lives. Two convoys, one starting in Brisbane and one in Toowoomba, will converge at Gatton Showgrounds for a day of entertainment and socialising on the Saturday. Then on the Sunday, a memorial ceremony will take place at Lake Apex Park.
Urana Vintage Rally & Truck Show Urana, NSW October 19-20
Head on over to Victoria Park in Urana for the annual Vintage Rally and Truck Show. There’s something for everyone at this event, from vintage engines and tractors to trucks of all shapes and sizes, plus a hospital fete with coffee, icecream and more. There is lots of free camping for visitors and showers are available on site. Contact Garry Baffsky on 0408683111 of Justin Livingstone on 0423319488 for more information.
The Heritage Truck Association of Australia is proud to host the 2024 Beaudesert Heritage Truck Show, featuring a wide display of heritage trucks, tractors and cars, as well as trade stalls. On-site camping is available for exhibitors and stall holders. Tickets are $10 for adults, with free entry for children under 14. Opening hours are 10am to 4pm on Saturday October 19, and 9am to 2.30pm on Sunday October 20. Arrival and set up is available from 1pm on Friday October 18. For more information, contact Mark on 0448111105 or John on 0477499530.
Technical and Maintenance Conference
October 21-23
Docklands, Melbourne new.truck.net.au/tmc
As the trucking industry’s premier national gathering of technical professionals, fleet and workshop managers, technical regulators, mechanics and service technicians, TMC is your chance to stay up to date, avoid breakdowns, and potentially save thousands of dollars through better maintenance and purchasing.
Learn from the industry’s best through technical workshops, demonstrations and training, and check out the latest industry products.
Have you got an event you’d like included in the next Save the Date? Email all the details to kayla.walsh@ primecreative.com.au.

BY KAYLA WALSH
THE sun was beating down on the small country town of Wondai, Queensland recently as the annual truck show saw 58 rigs roll in.
Part of the Wondai Show, which celebrated its 105th event this year, truckies travelled from across the region to take part.
Organiser Lauren O’Neill told Big Rigs: “We had trucks coming from Theodore, Chinchilla, Toowoomba, all around the area.
“There was a great mix of vintage and new trucks and different models.
“There were a few more trucks that had been registered to attend that couldn’t ma ke it in the end due to work commitments, but we
were still very happy with the turn-out and how the day went.”
Awards were handed out across 12 categories, from Best Bling to Best Tribute, but S & J McMahon Trans port swept the board with its 20 walking away with a number of prizes including Truck of the Show.
“We had an amazing day out at the Wondai Truck Show,” said Jamie McMa hon. “A big shout out to the boys for all their efforts in making their trucks look schmick, not only for the show but all year round.
“It’s great to see the show growing in size each year, and we’ll be back next year - hopefully with the full fleet!”


MFT Haulage –Kenworth T909
4-9 Years 1. S & J McMahon Transport – Kenworth Legend T950
Brayjay Haulage –Kenworth T659
Jacob Sullivan –Kenworth T909
10-19 Years 1. Yesberg Earthmoving – Kenworth T909
2. Gleich Contracting –Kenworth T908
3. TJC Haulage –Kenworth T909 Best 20-29 years
1. S & J McMahon Transport – Kenworth T950
2. L & T Haulage –Kenworth T404ST Best Vintage Truck 30+ Years
1. John and Vicki Bock –1963 Mack B61
2. Evan Williams – 1966 Diamond T
3. TKH Haulage – 1970 Dodge
Best Local Rig South Burnett Region
1. Corbet’s Group –Kenworth W900 SAR
2. Cameron & Deb Retschlag – 1963 Mack B61
3. Yesberg Earthmoving – Kenworth T404 SAR Best Fleet
S & J McMahon Transport
Gleich Contracting 3. Corbet’s Group Best Lights 1. S & J McMahon Transport – Kenworth W900 SAR 2. S & J McMahon Transport – Kenworth T950
3. Yesberg Earthmoving – Kenworth T909 No Time for Shine
1. Dan Hillcoat –Western Star 4964F
2. Higgins Services –Kenworth K200
3. Duncan Rackemann –International R180 Best Bling
1. S & J McMahon Transport – Kenworth T950
2. S&J McMahon Transport – Kenworth W900 SAR
3. Gleich Contracting –Kenworth C509
Best Tribute 1. MFT Haulage –Kenworth T809
2. S & J McMahon Transport – Kenworth T909
3. S & J McMahon Transport – Kenworth T909
Truck of the Show
1. S & J McMahon Transport – Kenworth W900 SAR
2. Corbet’s Group –Kenworth W900 SAR
3. Yesberg Earthmoving – Kenworth T909
People’s Choice
TKH Haulage – 1970 Dodge




kenworth.com.au/legacy





IT’S often said that a person’s best friend is their dog – and it’s true. But when you’re behind the wheel, your next best friend is telematics technology that is designed to keep you safe and informed and be the best driver you can be.
If you’ve been in the industry long enough, you’ll remember when rules came in about fatigue, rest times and mandatory breaks. It mandated the need to fill in a logbook tracking work and rest times, which had to be handed to the back-office team for manual processing and record keeping.
The problem with paper is that it’s inconvenient, not intuitive, too easy to make mistakes and often leaves managing issues with work hours until it’s too late. With an electronic work diary (EWD) solution, all those worries are essentially eliminated. The solution spans an in-cab device that makes it a snap to enter your start times, breaks and when you finally clock off for the day.
Even better, an EWD removes the uncertainty around fatigue rulesets and when you should get some rest. It
automatically lets you know there’s break time coming up, allowing you to plan ahead for your day and letting you pull up at a rest stop to get a good meal and coffee instead of pulling up on the side of the highway.
The next step is video telematics, a solution that uses outward and inward-facing cameras that use built-in sensors and AI-based technologies to analyse footage via advanced driver assistance metrics. This provides a third eye on the environment around and inside the vehicle to help them be safer and make more informed decisions on the road.
Video telematics works for drivers, particularly the new generation of smart cameras like Teletrac Navman’s AI-powered IQ Camera. It’s a view on the road ahead as a smart camera will warn you if you’re following the traffic ahead too closely or braking too harshly. It will also let you know if you’re showing signs of drowsiness and can alert you if you’re in danger of getting distracted. But where video telematics benefits the most is that

smart cameras can help you to understand why drivers are following closely or brak ing harshly. It’s all about the context that it can provide beyond the data or analytics. Maybe a car pulled in front of you and slammed on the stoppers. Or perhaps an animal ran out ahead. A smart camera understands this by recording the event to back
Our digital fleet management solutions are designed to ease the administrative burden on your team, while improving your driver’s workflow. From digital documents right through to electronic forms, TN360’s suite of apps can help you and your business transform the way it works.
your side of events to prevent fraudulent claims. Your fleet manager has access to the footage almost immediately through the TN360 management platform, so they have
safety tool. If there is an incident, those at HQ will know about it and can call emergency services to help because they know exactly where you are and have a pretty good
ics and EWDs are a driver’s next best friend after theirtions are designed to help keep you safe, support the driver through an incident, and make you a better driver through feedback by being smoother and more efficient behind the wheel.


OFFICIALLY launching this month, Custom Air Group’s new generation systems are unlike any other product before it. A fully integrated control Interface, it features a 7-inch LCD touch screen custom installed within the sleeper cab and the ability to Bluetooth control everything through your smart phone. As well as remotely controlling the cabin’s temperature, the app allows you to control a range of other functions in cluding the digital television, cabin lighting, microwave, 240v inverter and more.
As Custom Air general manager Mark Shepherdley explained, “We’re moving away from the old analogue type of system and very much into the digital age. There is nothing else like our new climate-controlled inter face available in the current market.
“You can remotely or local ly start and stop the Custom Air, set auto mode or manu ally adjust the cabin tempera ture and lighting, turn your TV or inverter on, you can even fully control your ancil lary diesel heater.
“The system also does all of its own diagnostics, as op posed to previous versions, which required technicians to physically check and diagnose any technical issues.”

Mark says Custom Air first moved into sleeper cabin air conditioning systems around 12 years ago, continuing to develop and refine their systems along the journey. “The latest extension of Custom Air’s innovation is the new Signature Series control interface that’s about to hit the market.”
Based in the northern suburbs of Melbourne, Custom Air specialises in heavy vehicle sleeper cab air conditioning systems and customised
Custom Air is owned and operated by Justin and Jacqui Liddelow, who acquired the business in November 2022.
Since then, it has seen phenomenal growth. In just over two years, Custom Air has more than doubled its output of air conditioning systems and cabin interior customisations. And, more recently, the business expanded its presence into Brisbane, with a second Custom Air site opening in the suburb of Rocklea.
“Queensland has always been a big market for us with strong dealer and client support,” added Mark. “It would
facility branded Custom Air Queensland, and managed by Kurt Dorant alongside his technical team.
“Our Melbourne business has predominantly worked alongside Paccar and the Kenworth distribution dealers throughout Australia with the factory being based in Bayswater. In Queensland we are also very fortunate to be affiliated with brands such as Volvo, Mack, Mercedes-Benz, Freightliner and Western Star trucks to name a few, alongside the Kenworth and DAF dealers.”
Mark revealed that the new


said Mark.
“Another six new generation units have just gone out and we’re getting fantastic user feedback. We also have 17 trucks lined up to be fitted with the system during August/September. It’ll be a gradual transition from the older unit to our new generation Signature Series.”
At the Somerton factory, approximately 38 full time technical staff work on every aspect of the assembly, production and installation process, using state-of-the-art machinery and equipment.
The Somerton facility features six bays for air conditioning installations and a further three bays for sleeper cabin customisation. Queensland features eight installation and service bays. Currently, Custom Air Group employs over 45 full time staff across two states. Internally it averages about 75 full A/C and cabin fit-outs a month, alongside product distribution throughout Australia and NZ, utilising its authorised sub dealer network.
“Custom Air Melbourne
Australia today. Our bunk customisation consists of additional factory look and trimmed storage cupboards/ also experiencing growth at the Brisbane facility. “There haven’t been as many cabin fit-outs up there in Brisbane








BASED at Caboolture in Queensland, Northside Diesel is now under new ownership – with Michael and Chris Sage taking over the business at the end of 2023.
From its 10-bay workshop, featuring all the latest technology and equipment, Northside Diesel specialises in providing top-quality servicing, repairs, and maintenance for trucks of all makes
and models. That’s in addition to being a service agent for Volvo, Mack and UD Trucks, along with having service agreements with various other suppliers too.
The business sits on a oneacre piece of land, with 1000 square metres of undercover sheds.
“At Northside Diesel, we specialise in anything with a diesel engine – from trucks
and machinery, through to cars and motorhomes. We have a six-bay truck work shop, a three-bay automotive workshop and a wash-bay,” explained Michael.
“Our main body of work are the owner operators and small fleets, but we do have numerous large and midsized fleets that use our ser vices too. Customers can ring us any time and know that




here happy with the level of service they’ve received, so we can create repeat business. We’re here to look after our customers and invite any new customers to come and speak with us.”
Michael added that every
workshop with the latest diagnostic tools and equipment. This cutting-edge technology enables Northside Diesel’s skilled technicians to accurately identify and address even the most complex mechanical and electronic is-






equipment and technology coming through,” he said.
“As trucks continue to change, we’ll keep changing and adapting as well.” For more information, please visit northsidediesel. com.au or call 07 5495 4133.

AUSTRALIA’S leading designer and manufacturer of high pressure water blaster equipment is launching its FREE safety training course, Aussie Blaster Safe Operator.
Australian Pump Industries has long been concerned with safety for operators of high pressure cleaners. The Aussie Pump range of pressure cleaners, sold not only in Australia
tic and export attention, the company realised that safety in the use of the equipment is an essential part of the package.
When Australian Safety Standards were introduced to protect operators in the workplace from potential serious injuries, training courses for Class B operators became compulsory.
machines without training of any kind,” said Aussie’s chief engineer, John Hales.
Aussie Pumps produced their own training program for Class A operators, Aussie Blaster Safe Operator.
The course promotes safety awareness, explains high pressure water technology, covers simple machine maintenance, and aims to prevent misuse of




“It’s our contribution to the industry,” said Hales. “We provide this free training program to all Class A users, regardless of the brand they are rating.
“We are always open to listening to feedback from end ers and through this realised there were some extraordinary risks being taken by untrained
operators,” said Hales.
“Our aim is to prevent injuries by training operators to identify hazards and in understanding how the equipment works.”
It takes less than half an hour and when completed participants will obtain an Aussie Pumps Certificate of Completion.
Further information on Aussie’s complete range of high pressure cleaners in both hot and cold versions, is available from Australian Pump Industries. Call 02 8865 3500 or visit the website at aussiepumps. com.au.






The ATA’s 2024 Technology and Maintenance Conference is fast approaching –here’s everything you need to know about the upcoming event.

THE ATA is gearing up to launch its 2024 Technology and Maintenance Conference (TMC) on October 21-23 at the Kangan Automotive Centre of Excellence in Docklands, Melbourne.
Sponsored by PACCAR Parts, the event is the trucking industry’s premier national gathering featuring truck service and maintenance professionals, from fleet and workshop managers to technical regulators, mechanics and service technicians.
With over 400 attendees, more than 30 speakers and 150 companies in attendance, the event shares the latest in truck maintenance technology to enable operators to minimise breakdowns and save
There is a host of great speakers on the lineup for TMC 2024 – here are just two examples, and what we can learn from them.

prestigious Castrol Awards Dinner, which celebrates the leading lights in truck industry workshops.
This year, the ATA will be bringing back the PACCAR Parts Fun Night to the cherished Fox Collection Classic Car Museum.
Attendees can enjoy an exhilarating evening networking with peers amongst some of the world’s most prestigious vehicles. The night also features the opportunity to participate in large-scale slot car racing, sit-down Daytona USA machines with plenty of exciting prizes to be won.
TMC’s plenary sessions will focus on supporting innovation to reduce truck emissions, creating thriving work-

among many others. Check out the full program at: truck. net.au/tmc/tmc-program.
Join us at TMC 24 and ex plore industry best practice and expertise through:
• Interactive hands-on demonstrations and training owcase of the latest products and services at the TMC EXPO lusive networking opportunities, such as the PACCAR Parts Fun ance to dress up and celebrate the indus try’s finest at the Castrol Awards Dinner.

Chris Loose
Chris Loose has spent his professional life absorbed with trucks and the product planning involved with them.
His first job among several truck manufacturers was with Isuzu, after graduating as a mechanical engineer from Melbourne’s Monash University.
International/Iveco followed, then a decade-long stint with Mercedes-Benz Australia looking after the Sterling and Freightliner products.
This was followed up with a stint at the ATA, then the Truck Industry Council and now he’s almost retired, but still sharing his vast knowledge.
Chris will be running an informative session on “Side Underrun Protection: What you need to do.” Attendees will explore what side underrun protection devices are intended for, the ATA’s guidance on side underrun protection, including clarifications sought by users, and the results of the engineering validation of the ATA’s construction advice.
Karyn Welsh
Chartered Institute of Logistics and Transport Australia
Karyn Welsh has been the CEO of the Chartered Institute of Logistics and Transport Australia (CILTA) for the past six years.
Karyn’s background spans major accounts and corporate strategy, while becoming heavily involved in the multi-corporate e-commerce platform CorProcure. She has authored several international papers and led one of Australia’s first e-freight market places.
At this year’s TMC, Karyn will be speaking on the topic of safety standards for construction trucks after operator registrations under the new Australian construction logistics standard, CLOCS-A, opened in July.
You’ll get the details of the new standard and find out how governments are already improving road safety as they build major infrastructure projects.

Whether you’re planning to attend just for the day, explor ing our new Fun Night +One day combination pass or keen on a full 3-day conference ex perience, secure your ticket today at truck.net.au/tmc.




FOR forklift and access equipment business AdaptaLift, its recently installed FleetCAM Artificial Intelligence vehicle camera technology from WHG have already proved their worth within months of being installed.
Since its founding in 1979 as Forklift Engineering Australia Pty Ltd, Adaptalift Group has continually grown its product suite and service offering to become one of Australia’s largest privately owned forklift, access and industrial cleaning suppliers.
It offers a full range of services to its national customer base including sales, rentals, spare parts and servicing from its network of metropolitan and regional branches and service centres.
Due to the size and type of equipment as well as the industries it operates in, the safety of company employees and the people who operate around the machinery is a non-negotiable for Adaptalift Group.
The group has invested significant capital into its rental fleet in the last five years in response to exponential growth in demand for rental solutions, now boasting a rental fleet of 3000 units nationally.
“People can rent our equipment for a day, a week, a year,”
said Adaptalift transport manager Aaron Navani. “Our trucks are primarily used to deliver and pick up forklifts, booms and reach trucks for our customers.”
Adaptalift currently has five trucks in total as part of their growing transport fleet with two prime movers and three tilt tray trucks in use nationally.
Two of these trucks have been fitted with FleetCAM as a complete vehicle monitoring system, with the remaining trucks to follow. The FleetCAM system includes five cameras fitted to each vehicle, including a fatigue monitoring camera in the truck cabin, with video recording and back to base reporting.
Aaron says when he was looking to have a camera system fitted to Adaptalift’s truck fleet, he came across WHG’s FleetCAM system after it was recommended by one of the company’s transport contractors. And he hasn’t looked back.

An in-cabin vehicle display for the driver shows the cameras around the vehicle to support visibility when reversing, loading and driving.
The footage captured via the five-camera system feeds into
“FleetCAM gives us peace of mind. We move heavy equipment that can weigh anywhere between 2 to 20 tonnes, so things can happen and they can go wrong. In the event of an incident, it means we are given a clearer view of what happened and if there are any areas we can possibly improve.”
an easy-to-use portal, accessible via smartphone or computer. Aaron says WHG provided training on how to use the portal and make the most out of all of its features.
He added that the technology is also helping with training and continuous im-



provement within the business too.
“It means we can look at what we can do better, how to approach certain situations, who to call and what to do. With the contractors we engage with, it means we can ensure they follow our policies and our guidelines.”
From a safety point of view, Aaron said FleetCAM’s fatigue monitoring technology is a great feature.
“Operators are driving machinery up and down off the truck, using heavy chains. We have a system set up to alert us if there are any fatigue related issues – yawning, distractions, braking or accelerating too hard.
“We also receive an alert if the truck is at a standstill for more than 45 minutes, as
WE MOVE HEAVY EQUIPMENT THAT CAN WEIGH ANYWHERE BETWEEN 2 TO 20 TONNES, SO THINGS CAN HAPPEN AND THEY CAN GO WRONG.”
AARON NAVANI
eras, so we could go through their placement. They’ve also been readily available if I’ve had any questions and will always pick up the phone.”
This attention to detail and professional installation provides an OEM look and feel in how the FleetCAM system is fitted to the trucks. AdaptaLift’s adoption of FleetCAM has quickly

WITH OVER 30 YEARS OF EXPERIENCE SUPPLYING TO THE HEAVY TRUCK AND BUS BULLBAR AND BUMPER BAR INDUSTRIES.
ACM can recommend a bumper or bullbar to suit your specific requirements. With a huge range on offer, we can match a product to your vehicle that will not only perform to the highest level but is backed by quality materials and manufacturing processes in the industry.

BY GRAHAM HARSANT
THE Livestock and Rural Transporters Association of Victoria held their annual conference at the MOVE Museum, Shepparton from August 16-17.
Updates on the industry, included the likelihood of ASLA (Aust Livestock Saleyards Association) and ALPA (Aust Livestock & Property Agents Association) combining into one association for the saleyards, going forward.
There was discussion on the use of electronic tags for sheep and cattle, where the proposal to use low frequency tags is being fought against, as it only allows for single lane downloading ramps.
The American system of high frequency tags means wide downloading ramps with the obvious gains in productivity.
Guest speakers included Warren Davis, ‘The Unbreakable Farmer’, who spoke about mental health and Dr. Dennis Desmond, a former American army veteran and FBI special agent who delivered a paper on cyber security.
Foremost on the agenda however, was the LRTAV’s breakthrough regarding PBS
for the industry. Association president, Russell Borchard, spoke of the success the association has finally had in achieving a higher Productivity Livestock Vehicle Scheme for Victoria after many years of lobbying.
“The current PBS scheme just didn’t work for the livestock industry. Under that system we couldn’t get 4.6 metre vehicles across the line without huge cost. One operator, Anthony Boyle spent $300,000 to meet the scheme - and it is working for himbut it’s totally out of the equation for the small operator to spend this type of money. We don’t have set work and set runs like others in the transport industry; our job changes constantly.
“So we’ve worked with the Department of Transport (DoT), Victoria and the NHVR over the past three years to come up with a viable option for our industry, and now have an accreditation scheme that our association will administer.
“We have proved our safety, we’ve been through all the tests and this will make it so good for our members for long distance cartage. It’s not something that we’re going to
use locally, doing short runs around Victoria. But Victoria has most of the abattoirs and there is so much stock that comes in from New South Wales, the Northern Territory, and out of South Australia.
“Now the trucks are going to be able to get to their destination without splitting up which makes for cost-effective, safe transport. Victoria has been 10 years behind the rest of the country until now, so this is huge. I guess the relief of it finally eventuating got to me.
“We’ve had to jump through all the hoops to make sure it’s safe, get it all signed off and get everybody on board with it – the DoT, the NHVR and Road Safe Victoria - but they have worked with us to make it viable for the industry.”
As an illustration of the costs involved under the current PBS scheme, Anthony Boyle described his personal story.
“If I’d known the costs and how long it would take, I’d probably not have started the journey. But I got to the point where I couldn’t go back.
“It cost me about $300,000 to get vehicles approved, which basically gave me access from Mount Gambier in South Australia to Warrnam-
bool on the Princes Highway, and then back through Melbourne and up through Shepparton into New South Wales. So I had all of two roads that I could use and just six trucks approved for that money.
“The process of gaining network access, getting over bridges and getting approval for existing equipment, instead of going down the path of new designs, etcetera was tedious and very long.
“Then, just when I thought I had all the boxes ticked, there would be another pop up and I was up for another $15,000 bridge assessment. Even though there were other trucks using them every day, I had to keep paying and paying.”
Boyle also had to pay for rollover and stability reports, and build a program around how to load the cattle to keep the weight down on the trucks.
Originally, every trailer was also assessed individually.
“I had to go through an assessment to verify that as a combination, the B-triple was actually more stable than a road train, or an A-double. I had to keep putting money in to prove those sort of things.

“Fortunately now, none of you are going to have to do that – you’re not going to have to get a bridge assessment on networks. It is so much easier now, and as long as you tick off your equipment you are basically right to go.
“You have no idea how much easier and more quickly you will be able to get your equipment on the network now. Is it frustrating to see how easy it is and what we had to go through to get that point? Yes it is, but I’m glad that you guys have an opportunity now to utilise the network as it should be.
“You are still going to look at it for the first time and says that it’s a bit daunting, but nowhere near as daunting as the original PBS phase 1. Thank goodness the road regulators have seen a bit of common sense. There is still a long way to go but by gee, we’ve come a long way.”
Russell Borchard said Anthony’s story illustrates why the current PBS doesn’t work for owner-operators in the livestock industry.
“What we’ve done is not going to work for every operator in this room. You are not going to be able to use this to cart out of Ballarat to Gee-
long, for instance. This new system is to create productivity in Victoria, where people are coming from longer distances.
“We are not expecting drivers to load road trains and run 50km, but we were so far behind others in the industry, such as grain carriers and general carriers with the current PBS, which didn’t work for rural carriers or for an owner-operator who’s got a Cannon stock crate or a Byrne stock crate with different axle spacing’s. The powers that be finally said, ‘What the hell do you need?’
Russell said there were two objectives put forward: One was an accreditation system and the other, an income stream for the LRTAV to survive and grow.
“We need to be able to employ people in the association to help us.
“The DoT threw in $25,000, we matched that and we did reports. This was all through the help of Anthony who’d already been through it and guided us along the way. For three years it went backwards and forwards through DoT and the NHVR and then back to DoT. It is now signed, sealed and delivered that we



MOVE Museum, Shepparton, August 16-17

can operate safely.



“We want to use equipment that we have. We wanted to be able to use existing equipment to turn a B-double into a B-triple, or turn two singles into an A-double - so you can put a Byrne A-trailer in front of a Cannon B-trailer or vice versa, so when bridge assessments are being done, you should be able to just hook one of your units up. We have set it up with Road Train Dollies when you’re using A-doubles, so that the drawbar’s short enough that you can use load-through and drivers don’t have to unhook.
“Believe it or not we even got a 42 metre unit through, from South Australia to Mildura to link up with the South Australian network and hopefully New South Wales is next. This is ground-breaking for our industry!
“Again, this isn’t something that is being designed for people to flog drivers doing short work; this is for interstate. We have so much stock coming into Tongala from Alice Springs for example - we have stock moving everywhere and we need the productivity.”
What will it cost?
“We’ve developed the accreditation system, so this is also built on increasing the membership of the LRTAV. Simply put, if you’re a non-member you will have to pay more. If you are a member of our association or South Australia or NSW you will benefit.
“At today’s rate it will cost you $500 for your accreditation package – a once off fee. It will cost you $300 per piece of equipment, per year to the association. Compare this to the $300,000 spent by Anthony.
“We’re going to have stickers on the truck, so the accreditation goes on the back of either Maintenance Management, WA accreditation or Truck Care. We have thought about it very seriously; some people may have one or the other, so it’s just an add-on module.
“Your vehicle has to comply with Euro 4 or later. Your trailers have to have either load proportioning valves or EBS to be PBS compliant.
You can’t get an old B-model Mack and run road trains through Victoria. This is for professional carriers.”
The LRTAV has done an immense amount of work to make the toils of livestock carrying in Victoria not only much cheaper, but far simpler.
Once you get your accreditation number you apply for a permit. Instead of everyone having to apply for individual roads you apply for a (3 year) permit for the DoT map network.
As an example, Craig is accredited and he has a feedlot he wants to get into. He rings the LRTAV and tells them where it is. LRTAV apply through DoT to get that road added to the map instead of Craig applying.
Once that road is added to the map anyone with a permit can automatically go there, so if Craig’s brother has accreditation he can go there too. This gets rid of the rigmarole of going for permit after permit. The accreditation is easy and is a huge leap forward.
“If any abattoirs want to get online, our association owns that mapping,” said Russell. “We’re the one that goes back to LAM, to where we get roads accredited. So any abattoirs that want access, if they want us to get their road added on so that someone can go in there with a Road Train or B-triple, they have to allow the LRTAV access to do an audit on that facility. It has to be audited that you can get an A-double or a B-triple in without unhooking.
“We don’t want livestock trailers parked on the side of the road causing us animal welfare concerns. We don’t want drivers having to be splitting up, so they must allow us to go in and inspect their facilities.
“We’ve also written into it that we have to inspect ramps. This is a tool we can use for abattoirs to become compliant, because they will want these vehicles in there for long-distance livestock travel. This is about safety as well.
“These initiatives will create an income stream for our association so it will take pressure off memberships. Everyone in this room today wants to be a part of this.
“The people that aren’t here, who don’t want to be part of the association and don’t want to help, have been riding off the back of associations like ours for us to fix stuff up for them. So this is going to be a good tool for this association moving forward.”
Under Russell’s watch the LRTAV has had some great wins for the industry but still has hurdles to climb, or as Russell put it, “brick walls to knock down”.
We wish them well.


RECENTLY we found ourselves back on ‘The Big Island’, aka Australia, and it was a great pleasure to catch up with many friends from our ‘old days’, of stopping for a chat and discussing developments in today’s industry.
Despite a lot of hype, it felt very much the same as the ‘Old Transport Industry’ of 1986 when I owned my first truck, mainly still the same friendly faces and names on trucks, both marquees and companies.
Most drivers complained of the pressure to meet time slots and comply with the ever-increasing burden of regulations and the demands of a booming bureaucracy.
But none the less it was great getting out on the road again, and here is a selection of brief, but much appreciated, interviews from our road trip.
Time to hang up the driving boots
Dropping in to the BP Roadhouse at Tailem Bend recently, it was an absolute delight to run into Danny Dier, whom I have known for about 28 years.
We stopped for a cuppa and during this time Danny told us he had recently sold his last truck, a reliable DAF XF95 with a 1.3 trouble-free million on the clock, and after 52 years as mainly an owner-driver, he felt it was time to hang up his driving boots and enjoy life.
met all those years ago,” Danny said.
“However, I never did carry general freight, sticking to the easier loads. I have been selling off my gear and trailers etc, bit by bit for a while now, and the last thing to go was the truck.”
Danny said it seemed altogether a good time to step out of the industry, which is not at all like it was when he started driving.
“Much more bureaucracy, less now a life vocation than just a job, and a stressful one at that with continual paperwork.
“No more stops on the side of the road to chat with a mate or help change a tyre, and a lot of the job satisfaction has gone.
“It is practically a full-time job keeping up with the constantly changing regulations and restrictions, and everyone is working to time slots.
“It has been a great job for 52 years, though, and I’ll miss the driving and the mates along the way, but now it feels time for some recreation and quality home time with Gail, my wife, and family.”
Still enjoying it after 30 years
Well, the rain had stopped briefly and stopping at the Tailem Bend Ampol, we caught up with John Liles from Cootamundra when he also stopped over for a quick cuppa. He was driving a Farey’s
on his way from Adelaide to Naracoorte and then back to Wagga Wagga.
“I’ve been here for about 12 months now, and I’d have to say this is a great family out fit and they look after their trucks, their gear and their drivers,” John said.
“I have driven for several companies but Farey’s have been by far the best. I’ve been on the road for 30 years or so now and I am still enjoying it.
“I guess I started working in the industry when I was work ing for a fellow doing hay back in the 80s, that got me started but it’s also in the family.”
John said he’s mostly happy enough about how things are going but there are undoubt edly some problems that need addressing.
“Certainly too much bureau cracy on the one hand, but, for example, some of the results of trustingly accepting foreign licences to fill in for the short age of experienced drivers, has in fact seen some unnecessary accidents, even leading, in one case, to tragic consequences.”
Looking ahead to new chapter It was great to catch up with Henry McMurray from Keith in South Australia the other day when he pulled over for a quick refreshment break near Tailem Bend.

Our eye was instantly caught by his Brecon Transport 2009 T608 and he was towing a nicely detailed tri-axle drop deck trailer at the time.
He told us he was on his way to Murray Bridge for a load of lucerne hay, and then would be taking it back to the dairy and then home.
Henry told us he had started life out as a diesel mechanic, did some farm work and odds and ends and had been driv ing for some time before com ing to work for Brecon’s.




This, he added, was their only truck but they have al ways kept the maintenance up on it and all their gear.
“I couldn’t have found a bet ter boss or outfit to work for,”
Subsequently Henry took his wife and family abroad, but on his return, there had been a shift in the company’s direction meaning that his job would be more focussed now on the broadacre and livestock side of the opera
He said he had loved the truck and the driving itself and getting out on the open road, and he would miss it, but he was looking ahead to a new chapter.

Loving life on the road
At Tailem Bend we were fortunate to catch up with Ryan Little from Freeling when he stopped over for a welcome hot cuppa at the Ampol roadhouse there.
He was on his way from Davistown to Coomandook,
to Victoria, then back doing chicken feed, and driving a Lauke’s 2017 T610 with a Cummins up front and towing a tri-tipper over axle trailer.
“I came here to fill in about seven months ago for a driver who was away with health issues, and I’ve been here ever
“It has been a great number, not too stressful, and they really look after all their drivers as well as the gear.”
Just after this chat, the bloke he was relieving returned, fortunately well again, but Ryan happily found a job straight away driving for TML doing general freight
Adelaide and Melbourne, and he tells us he is equally happy there, and enjoys the regular work.
“I’ve been driving professionally now for 13 years and am still happy with getting out on the road, it’s what I always wanted to do and it still suits me.”





A family man on a mission is how I would describe this issue’s feature driver.
Stepping back from the big trucks for a change and sharing Scott Purchase’s story.
Purchase has been driving for seven years and is currently driving a 2021 Isuzu for Peter Sadler removals.
It all started when Scott was 13 years old back in the 1990s where folks ran their own business transporting furniture from Melbourne to Adelaide.
Scott was looking after the office area of the warehouse in Horsham until they shifted the over to Melbourne.
After a couple of years he took a break from furniture removalist work and his family moved to Queensland.
It was there Scott became a jockey for Allied Pickford removals learning to drive in one of their trucks where it also keeps him quite fit.
In time Scott returned to Victoria taking up his current role with Peter Sadler Removals and Logistics.
He was given the opportunity to get his heavy vehicle licence and he’s not looked back.
It’s a diverse position he is
currently undertaking having gone from a jockey to being a driver learning delivery routes, from dropping off beer kegs to doing retail Harvey Norman work and aged care health equipment with a company called Aidacare.
When it comes to Scott’s favourite roadhouse he swears by the bp Goondiwindi Queensland and his go-to feed is the big truckies meal with the ‘lot’ every time.
Scott is big on safety and at the start of each day without fail he does a full pre-start check on his truck and its systems then he’s ready to rock and roll.
Looking out for each other on the road is also something he’s big on and is always there for others.
Away from the daily grind, Scott spends his time with family and enjoys the downtime.








AS the saying goes, variety is the spice of life. And that’s one reason why the remote Duchess Hotel in north west Queensland is popular for truckies who are in the area.
Duchess is a small town with a population of 60, situated on the mostly dirt 170km long Cloncurry to Dajarra Road in north west Queensland.
Veteran driver Laurie told Spy it was a great place to stop for a number of reasons.
“The owners and staff are friendly, the drinks are cold and you get treated with bush hospitality,” he said.
Spy has been there and can verify that. In the bar you will also meet many characters who have a tale to tell.
I spoke to publican Mick Jess who runs the pub with his partner Fleur Brown.
“We get a lot of different trucks stopping here, mostly Kenworths. But also Volvo, a Peterbilt from Cloncurry and the odd Mack,” Mick said.
He added that there was a variety of meals on the menu including something different at nights.
“Last night we had Chinese food, and truckies love crumbed steak or rump. But they appreciate a choice,” he said.
Mick added that the road gets graded regularly and is in general good condition.
“We had a lot of water trucks stop here this week,” he said.
Cloncurry Dajarra Road commences at an intersection with the Barkly Highway.
Duchess is surrounded by a number of pastoral stations including Mayfield station and Stradbroke station. Fleur’s family also has a big property nearby.
Small operators facing difficult times
Reports meandering their way to Spy from Tasmania are that many small fleet operators and owner drivers are doing it tough, with some facing financial ruin.
“I have never seen it such a





struggle to get work here,” one long time veteran told me.
I asked why and he said there were a number of reasons including high interest rates, fuel prices and some counterparts accepting super low freight rates.
To steal a well known comment from politician Pauline Hanson I asked, “Please explain”.
“The other day a regular client wanted me to deliver from Hobart to Strahan on the west coast and when he received my quote he advised that somebody else had offered him a rate which was $900 cheaper,” the truckie said.
“So he accepted it and I
warned him that it may not be a good decision. It costs me $1130 for fuel for that trip.”
A week later the client phoned my informant asking him if he’d make a similar delivery, advising the low-rateman had not worked out.
“I told him it would be an extra $200 for the trip and he had to take it,” he said.
Another well known Apple Isle operator said some people who thought they would make a quick buck purchased a truck.
“Then they find out that it is hard to keep up the monthly instalments when you are only working seven months a year instead of 12,” he said. Fuel costs were also an ob-
stacle with the bowser price of diesel around $2.10 a litre when we spoke.
Some ease that financial burden a little by purchasing their fuel at high volume outlets like one at Campbelltown on the Midlands Highway, or another in the Huon Valley.
“I can save 2.6 cents a litre there which adds up. The fuel at Campbelltown comes by road from Hobart where it is dearer,” he said.
Similar fuel dilemma
Spy has a similar query regarding fuel costs between the Queensland outback and the east coast.
There is a big fuel depot at
Townsville and you can often see fuel trucks from Julia Creek travelling to the coast and filling up tanks at various outlets.
You would expect that the fuel would be similar in price out west when compared to Townsville.
Not so. Fuel in North Queensland’s biggest city is around 30 cents per litre cheaper.
So what’s the explanation? That I do not know.
Goodwill act by fuel supplier
A long-time fuel supplier for a small road transport company was responsible for an act of
The company owner had passed away and the business




was left to her son in her will.
After her death the company was still an ongoing operation with several trucks running.
It would take some months for probate of the will and for the bank accounts to be changed over.
Anyway the fuel supplier heard of the circumstances and offered the son credit on all fuel, even if it took six months.
He was overcome by the gesture from the fuel supplier, which he had dealt with for decades.
In the final analysis he didn’t require any credit as he had funds of his own.
But it sure was appreciated.
Mount Isa fuel cheaper than Charters Towers
The outback mining town of Mount Isa is 900km from the coast and Charters Towers is 780km away.
Both towns are road transport hubs with many trucks passing through them daily.
Being so far away, many would expect fuel at Mount Isa to be much dearer than at the Towers.
After all, at the towns between them – including Hughenden, Richmond and Julia Creek – it is more expensive than at Mount Isa.
A veteran owner operator with 50 years of experience tells me he purchases fuel at Mount Isa for 10 cents a litre cheaper than at his home town of Charters Towers.
“I travel to Mount Isa a lot and take as many cans as I can out and buy fuel there,” he said.
It is very difficult to determine how and why such prices vary.
Drivers in the poo
To say some drivers of livestock trucks are in the “poo” with others would be an understatement.
These are the ones who empty tanks which contain waste from the livestock mixed with liquid at rest areas.
Old Spy thought that most livestock transporters hosed out their trailers containing the waste when they are at a designated area such as sale

yards. That is a dirty and smelly job and Spy has actually snapped pics of such activity.
But angry drivers have contacted Spy to express concern about the dumping of waste at rest areas.
“I was at a pull off area north of Bourke in NSW and a driver emptied his tank right near where I was eating and then took off,” a Victorian truckie told me.
Another said that a similar incident occurred near Augathella in Queensland.
I hope this is not a “waste” of time and the culprits read this and have more concern for others in the future.
Wishful thinking about Bruce Highway
Is it too much to hope for a long-term multi-billion-dollar commitment from the federal government to upgrade the Bruce Highway?
At a bush summit in Townsville, Prime Minister Anthony Albanese said that finally an end may be in sight for suffering Queenslanders who have long campaigned for a much needed upgrade.
Most truckies Spy asked about the worst roads nominate the Bruce Highway which has claimed many lives.
Albanese said it “needs to be done” when commenting on the substantial funding needed to fix the Bruce Highway.
When asked why all three major highways in his home state of NSW are now dual carriageways while the Bruce in Queensland is not, Albanese said those changes


one said. The lads generally tow a small aluminium dinghy with an outboard motor to use as well.
They also do a spot of crabbing and generally catch some nice big male bucks which make great eating.
It is a time of genuine relaxation and recreation for these mates but they are never far away from the road transport industry.
Over the years they have got to know some of the truckies who deliver to the remote regions.
occurred while he was infrastructure minister and he admitted the Bruce upgrades commenced at the same time.
“What I don’t want to do, and people don’t need in this country, is media releases that make claims that then don’t get delivered,” he said.
“I want to do it as soon as possible. I want to work with the Queensland state government in doing that.”
Fixing the Bruce Highway emerged as the number one lingering issue for regional Queenslanders at the summit, with Albanese saying substantial funding was now “on the table” for the highway.
“There is more to be done, it is a long road and it will re quire substantial funding, and it won’t be done overnight, and it won’t be done in one term,” he said.
A group of truck drivers from around the Newcastle region of NSW are going to take extra precautions when they travel to the Gulf of Carpen taria for their annual fishing expedition soon.
They travel in a small convoy of four wheel drives to take ad vantage of the dry roads before the wet season closes them.
In past trips they have camped close to waterways and fished from banks nearby.
But a spate of crocodile at tacks on humans has ensured they will be more careful this time.
“We will all set up camp away from the creeks or rivers and fish from a safe distance,”

three states and have included sightings of some of the poisonous species. Authorities say that snakes usually become more aggressive during their mating season and should be avoided if you come across them.
There is a New South Wales rest area beside a paddock where numerous sightings have occurred.
Apparently people leave rubbish, including food, which overflows from full bins onto the ground.
This attracts plenty of insects which snakes love.
Reports have slithered to Spy about snakes being active around rest areas which are near the bush.
Spy saw a woman run from a toilet at the Mingela rest area after finding a snake inside.
ing a venomous snake when he pulled up outside the Belyando Roadhouse on the Gregory Development Road.
Dangerous load and dangerous driving
From WA comes a report about a truckie who was travelling along a road near Auski Roadhouse when an idiot overtook him in a very dangerous manner.
“It was another truck which was overtaking me and I had to pull off the road as another rig was coming in the opposite direction. There was almost a head-on collision and it was just fortunate I had space to move over,” he said.
ilous was that the culprit was -














YOUNG driver Money Singh did not dodge the subject when I asked him for a comment on criticism of Indian truckies by many Australian counterparts.
“If Indian drivers do the wrong thing they deserve criticism. I seek as much advice as I can get from Aussie drivers I see and I come across mainly veterans and love the job here,” he said.
The 25-year-old truckie works for SLR Trans based at Brisbane and was parked up in his Mercedes when I saw him in Townsville late last month.
“The Mercedes has 300,000km on the clock and is good to drive,” he said.
The friendly truckie used to drive road trains in WA and has enjoyed a short stint in Queensland.
“But I return to WA soon to work for Bannu Transport which is owned by an Indian and based at Kewdale,” he said.
Born in India and from a big farming community in Punjab, he has lived in Australia since he was 18. He previously spent three and a half years working as a truck driver in WA, before moving to Queensland.
He had just transported frozen foods from Brisbane to Townsville and was picking up produce at Bowen for the return journey.
Money says his favourite roadhouses have been several in WA and Townsville’s BP Cluden, which is where I saw him.
Money added that the worst road he got along was in WA, between Leinster and Mount Morgan. Leinster is a town in the northern Goldfields area of WA, 968km northeast of Perth.

Commenting on hobbies outside of work, Money said, “My favourite sports are football codes and volleyball which I played in WA.”
This young bachelor says he is content on his move down under, “I love every day of it,” he said.
WHEN Big Rigs saw Warwick Jacobson at Charters Towers Gold City Roadhouse recently, he was walking towards his white Volvo.
“I have delivered general freight from Brisbane to Townsville and do the return trip once a week,” he said. Warwick works for his brother Craig’s company, Jacobson Transport, which is based at Cooroy in southern Queensland.
“This is the only truck he has and I drive it and he does the administration side. But when I go on holidays he takes over driving,” Warwick said.
The 55-year-old truckie was heading towards Emerald to pick up a backload of cotton for Brisbane.
“This is a really good truck and I like driving it,” he said.
A truck driver for 35 years, Warwick said the worst road
he gets along is the section of the Gregory Development Highway known as the Belyando.
“The shoulders are terrible and even though there are two rest areas along the way, more parking spaces for trucks are needed,” he said.
Warwick added that he cooks a lot of his own meals when on the road. “I don’t stop at many roadhouses for food,” he said.







GREG Andress, 62, drives a truck six days a week, mostly in the Queensland outback and on his day off puts his trusty shoes on and runs 15km.
This fitness fanatic also competes in long distance events and recently completed a 21km half-marathon in one hour and 50 minutes at a Townsville running festival.
Over the past three decades I have yarned to many drivers and would have to rate Greg as amongst the fittest.
Most people of Greg’s age
lawn bowls or golf rather than partaking in a sport like marathon running.
This dedicated truckie has worked for Cement Australia based at Townsville for 25 years and in June was the recipient of a special recognition award by the company.
“The state manager came up from Brisbane and gave a presentation, which was truly appreciated. I like my job and Cement Australia is a great company to work for,” he said. While Greg is slim and fit and generally in good health, he has fair skin and has had

several skin cancers removed by doctors. He advises people who go out in the sun to slip, slop and slap.
“Skin cancer awareness is important. In August 2015, I had an aggressive squamous cell carcinoma in my cheek muscle. I had an operation to remove it, then radiation five times a week for six weeks, which completely flattened me,” explained Greg.
“Cement Australia were very good to me during this period, allowing me to get to doctor’s appointments and treatment times. A massive thanks to the allocation team.
“I’m very lucky, I have made a full recovery and can keep working and doing my
hobbies,” he said.
When we chatted recently, Greg was parked up at the Townsville Port Access Road hook-up pad in his 2022 Mack Super-Liner.
“I have been out to a mine near Cloncurry and do western work most of the time,” he said.
He rates the 100km stretch of the Flinders Highway between Hughenden and Richmond as the most challenging to travel. “It is very rough,” he said.
Greg likes stopping at the Liberty Roadhouse at Richmond, 500km from Townsville.
“It has good road train access, clean showers and good food,” he said.

A health check of Australia’s heavy vehicle fleet
The National Roadworthiness Survey has been running across all states and territories and is due to finish in October 2024.
Once completed, authorised officers from the NHVR and partner agencies will have conducted random mechanical inspections of approximately 8,500 of Australia’s trucks, buses and Special Purpose Vehicles.
The National Roadworthiness program helps to drive safety and efficiency improvements to the mechanical condition of Australia’s heavy vehicle fleet.
For more information visit nhvr.gov.au/nrs

While running is his major recreation when off work, Greg also has a Harley Davidson bike which he gets to ride in events.
“On Saturday August 24 I rode my Harley Street Glide from Kurrimine Beach to Kurumba in a day. The weekend after I rode down to Thargomindah to start a five-day Poker Run,” he said.

Regarding football, Greg says he barracks for both the NQ Cowboys and Manly Sea Eagles in the NRL.
“I had a relative who played for Manly,” he said. So which of them would he support if Manly played the Cowboys?
“I live in Townsville so it would have to be the Cowboys,” he said.


PETER ANDERSON CEO, Victorian Transport Association
THE freight and logistics sector forms the backbone of Australia’s economy, moving goods across the nation and ensuring that businesses and communities remain connected.
However, behind the steady flow of goods and services are the transport workers - drivers, warehouse staff, logistics managers, and others - who face significant mental health challenges every day.
These challenges, if left unaddressed, can ripple through the entire supply chain, threatening its continuity and efficiency.
In recent years, it has become increasingly clear that mental health is just as important as physical health, particularly in high-pressure industries like freight and logistics.
Yet, despite the essential role transport workers play, mental health support in this sector has been lacking. The demanding nature of the work, coupled with long hours, isolation, and the relentless pressure to meet deadlines, can

take a severe toll on mental wellbeing.
Transport workers, particularly long-haul drivers, spend hours, if not days, on the road, often in isolation.
This extended period away from family and friends can exacerbate feelings of loneliness and depression.
Compounding this isolation is the physical and mental fatigue caused by irregular sleep patterns, poor diet, and the high degree of concentration required for the job.
The impacts of this go beyond individual suffering— poor mental health among transport workers can lead to decreased job performance,
higher absenteeism, and in the worst cases, serious safety incidents.
From a business perspective, the mental health of transport workers directly impacts the smooth running of the supply chain. When workers are mentally unwell, their productivity declines, and the reliability of the logistics network is compromised.
Absenteeism due to mental health issues results in delivery delays, missed deadlines, and additional costs for businesses that rely on the transport network to function efficiently. These disruptions can have a cascading effect, potentially leading to inventory shortag-
es, lost revenue, and damaged relationships with customers.
In addition to absenteeism, the turnover rate among workers struggling with mental health issues tends to be higher.
When employees leave due to mental strain or burnout, the cost of recruitment and training for new workers adds to the financial burden on companies. Retaining skilled workers is crucial to maintaining operational continuity, and supporting their mental health is key to achieving this.
For an industry that operates on tight margins, these indirect costs can be considerable.
The economic losses caused by a mentally unhealthy workforce far outweigh the investments required to implement proper mental health interventions.
Addressing mental health issues in the freight and logistics sector starts with recognising that mental health is an occupational health and safety issue. Employers must be proactive in promoting mental health awareness and providing access to appropriate resources.
This includes regular mental health training for both workers and management, as well as offering confidential counselling services for those in need.
Furthermore, fostering a supportive and open workplace culture is crucial. Workers should feel comfortable discussing their mental health without fear of stigma or judgment.
Unfortunately, in industries like freight and logistics, mental health is often viewed as a personal issue rather than a workplace concern.
Changing this perception requires leadership and commitment from employers to prioritise the mental wellbeing of their workforce.
Another important aspect is the role of government and industry organisations. There needs to be a coordinated effort to develop mental health programs that are tailored to
the unique challenges faced by transport workers. Policy changes, industry guidelines, and initiatives that support mental health can make a significant difference in how workers cope with stress, fatigue, and isolation.
Ultimately, supporting the mental health of transport workers is not a luxury—it’s a necessity. The freight and logistics sector cannot function without the people who drive it, and ensuring their mental wellbeing is vital for the continuity of the supply chain.
As the freight and logistics industry moves forward, mental health support must be at the forefront of our strategies to ensure a healthy, resilient workforce.
Supporting the mental wellbeing of our workers is not only the right thing to do but is also essential for keeping the wheels of the economy turning smoothly.




BIG trucks carrying large loads are what keeps Australia growing.
As a country we are in the middle of a major infrastructure boom, with state and federal governments across the nation pouring billions of dollars into super energy and renewable projects, while tur-
bo-charging plans for road, rail, bridges and tunnels.
Earlier this year Melbourne witnessed the incredible movement of a 477-tonne, 125-metre-long load from the Wilson Transformer Company in Glen Waverley, through the city and onto the Waratah Super Battery Project in New South Wales.
The vision of the extraordinary load navigating through the night was striking, with the sheer size meaning it often swept across multiple lanes, with roads needing to be closed.
While the load was scheduled at night to minimise disruptions for other motorists,
a movement of this size is always going to be challenging and require everyone to play their part on the road.

And as more projects get off the ground, the movement of Oversize Overmass (OSOM) vehicles carrying everything from transformers and wind turbines to mining equipment and major construction equipment, is predicted to increase.
It is why at the National Heavy Vehicle Regulator (NHVR) we have committed to a renewed focus on targeted safety advice towards both light vehicle drivers and fellow heavy vehicle drivers. Navigating an OSOM load comes with a unique set of challenges for both the driver, and the escort vehicles accompanying it.
While there are varying laws in different jurisdictions, in Victoria, NHVR Safety and Compliance Officers are the ones charged with provid-
ing escort services to OSOM transport.
It is a challenging and dangerous task, with the convoy of pilot and escort services combined with the load potentially stretching for kilometres across both urban and rural areas.
Whether drivers are approaching an OSOM load from the front or behind, it is imperative they begin to slow down and prepare to await instructions from the escort team.
Those with a UHV Radio should switch to Channel 40 where the pilot vehicle can relay instructions, which may include stopping, pulling over or overtaking when clear. Importantly, drivers should
ensure they only pass the OSOM load when instructed to do so, as not following instructions can quickly evolve into a dangerous situation.
One of the biggest mistakes we see is drivers overtaking an escort vehicle and getting stuck between the vehicle and the OSOM load – a hazardous scenario which puts everyone at risk.
By law in Victoria, all drivers should remember the requirement to slow down to 40km/h when passing vehicles with flashing lights – which specifically includes the NHVR’s flashing magenta lights.
Unfortunately, we know it is not only light vehicle drivers who need to be reminded to take extra care and precaution
on our roads when they are in the vicinity of an OSOM load.
Heavy vehicle drivers must too remain vigilant, and follow the same requirements of slowing down and following the instructions of any pilot or escort vehicles.
A collision or near-miss between a major OSOM load and another heavy vehicle has the potential to result in catastrophic consequences – a scenario no one in industry or the NHVR ever wants to see.
With more OSOM loads hitting the roads in the coming months and years, it is up to all of us to slow down, follow instructions, and make sure everyone makes it home safely.









umn in Big Rigs (‘Committed to transparency in all our investigations’, August 16) acknowledging the NHVR has work to do in communicating outcomes of investigations was pleasing; however, my criticisms about failing to prosecute a ‘Big One’ still stand.
Then there was media proudly trotted out about the National Roadworthiness Survey. Now, please do not misunderstand me.
I have no issue with checking the safety of vehicles. What I object to is the assertion that drivers need to factor in the 45 minutes indicated as being the amount of time taken to complete a check and that it isn’t a big deal. Really? My eye started to twitch. Read on, dear friend.
The NHVR completed the first National Roadworthiness Baseline Survey in 2016, with a total of 7130 vehicles inspected. In 2021, another National Roadworthiness Survey was undertaken, and a total of 8338 vehicles were inspected.
Like previous surveys, this one will no doubt throw up a heap of major, minor and grounded non-conformities.
In 2021 31 per cent of the fleet inspected had non-conformities, and it was 48 per cent in 2016. And everyone will pat themselves on the back at what a jolly good job they’ve done to protect the community from these poorly maintained, dangerous trucks.
Forgive my cynicism. Could someone please produce crash data that shows lack of vehicle maintenance contributes to the road toll? We know driver inattention, inappropriate speed for the conditions, and
fatigue are the three top factors in crashes, not maintenance.
Look, I know, I get it, the defected trucks are certainly better to have had the issue identified.
But it makes me ask, if the Australian truck fleet is so poorly maintained, why aren’t trucks inspected all the time, not just when there’s a survey?
What about the information gathered? Is this used to conduct investigations? If the operator has a truck that’s grounded for a safety issue, aren’t you curious about other trucks in their fleet?
And not to sound like a broken record, but what about those in the chain of responsibility who engage these operators? Shouldn’t they be investigated to find out what they’re checking when engaging these companies? What is the consignor/consignee doing about this?
I don’t mean those where there’s a cracked lens or a newly damaged windscreen, I mean things like bald tyres, so obvious a child could identify it.
These issues warrant a deeper look at an operator’s overall practices, not just a canary sticker and a tick in the regulator’s quota box that a truck was checked.
Operators who work hard to maintain their vehicles must be so frustrated when their vehicles are targeted for issues not affecting safe vehicle operation.
Accreditation doesn’t seem to matter either, especially if a pre-start identifies the truck was fine when it left the yard, and then an issue out on the road caused the issue being defected (e.g. cracked windscreen, lost mudflap, etc). All are apparently treated the same.
And all the time this takes! Tick tock, tick tock! We’re told 45 minutes should be factored into our day for these inspections.
Let’s put this into perspective shall we.
The 2016 survey didn’t have time estimates, so let’s use the 45 minutes being estimated for 2024. The 2021 survey data shows the average inspection time was 31 minutes.
We don’t know how many

an investigator has two years from the time an issue is identified, to the time charges are laid. Longer than that, and charges cannot be laid. Two years. 104 weeks.
In the table above, up to 3.4 years’ worth of enforcement resources are being used in a relatively short period of time to complete a survey that cannot demonstrate any effectiveness at lowering the road toll.
Imagine if those resources, funded by us taxpayers, were directed towards areas drivers have long complained about, such as waiting times
I’m keen to see the survey stats when finalised. If the measure of a successful survey was not how many non-conformities were found, but rather, how many lives it saves, I doubt another National Roadworthiness Survey would ever see the light of day.
But a significant prosecution, the ‘Big One’? That has the potential to change the future of the road freight industry for the better, with meaningful impacts on road safety outcomes.
Where would you rather see your taxpayer dollars spent?







BY KAYLA WALSH
CRYSTAL Stanbury was a self-described tomboy growing up, with a keen interest in trucks – but it never occurred to her to drive them for a living.
The Adelaide woman was working in admin when she decided she’d like a change, and one day her partner’s dad mentioned that he used to work for Hanson Australia.
“He said it was a pretty good job, so I thought – why not give it a go?” she told Big Rigs.
Crystal then applied to become a driver through Hanson’s Trainee Driver Program, and ended up being one of five new starters at the company in May last year.
Hanson paid for her to get her heavy rigid licence before she headed out in the truck, with more experienced drivers showing her the ropes until she was given the green light to go it alone.
“It was a big help that they paid for my licence, because it’s quite a lot of money,” she said.

job better.”
The 23-year-old now drives a concrete agitator, making deliveries from the Hanson plant to customers throughout the Adelaide area.
During her training, she
loaded at different locations,” she said.
“Some of them had screens where you could see if you had done it correctly, while others had a mark on the ground where you had to
DON’T BE SCARED. YOU MIGHT THINK YOU NEED TO BE REALLY TOUGH TO WORK AS A TRUCKIE, PARTICULARLY FOR A CONCRETE COMPANY – BUT JUST GIVE IT A GO.”
CRYSTAL STANBURY
park yourself.
“They were all different, so it was good to see how each place worked.”
She’s loving her job so far and said every day is different.
“You never know where you are going to go or who you are going to meet, which makes the job interesting.
“I think it’s the coolest thing ever.”
Although she is very happy in her role, she has thought about upgrading her licence in the future.
“I just take every day as it comes, but one day I might like to drive a semi,” she added.

Despite being a minority as a young female driver, Crystal finds Hanson to be a respectful workplace.
“I get along with everyone and they treat me with respect,” she said.
“The y shouldn’t have to change the way they do things because of my gender.
“Being a female in this industry, I don’t want to be treated differently – I just want to be treated fairly.”
Sharing her advice to other young people who might li ke to get into the industry, she said: “Don’t be scared. You might think you need to be really tough to work as a truckie, particularly for a concrete company – but just give it a go.”
To learn more about current traineeship opportunities at Hanson, visit hanson. com.au, or contact one of the company’s regional offices.

1. Contact Big Rigs to place a print ad in the careers section, with over 22,000+ copies printed and distributed nationally
2. Careers Ad placed online at www.bigrigs.com.au
3. Careers Ad amplified on socials with over 100,00+ Followers

BY KAYLA WALSH
THE Livestock and Rural Transporters Association of Victoria’s (LRTAV) Young Driver of the Year has said there are great opportunities for young people in transport, if you are willing to make some sacrifices.
Caleb Baldock, 29, is an interstate MC driver for Mibus Transport in the Wimmera, doing everything from carting livestock to oversize work to handling compliance for the company. He was named Young Driver of the Year at the recent LRTAV conference in
Shepparton, with his uncle and employer Daniel Mibus praising him for his extensive skills and hard-working atti-
“He’s not just a truck driver, he’s also a certified pilot driver for oversize work,” Daniel
“He handles all our permits and compliance, because he’s from a younger generation and he’s great with computers – where that just goes
“He runs the maintenance programs for us as well, and he’s right up with his me-
He added that Caleb, who joined Mibus Transport four years ago, is quick to help
“Say we’re chaining an oversize load on – he won’t just do it, he will always teach the person who’s with him why he does it that way.”
Caleb has a two-year-old daughter and another child on the way, and Daniel said his nephew has had to forego some family time because of his job, which brings him all around Australia.
“When you jump in a truck and you’re doing interstate

work, you don’t know when you’re going to be home,” he said. “Caleb has missed out on a lot, but he always has a positive attitude.”
Caleb said balancing family life and work is definitely a challenge.
“You have to make sure that when you are home, you give time back to your family and enjoy it because if you miss it, you can’t get it back,” he said.
“My wife is very understanding of the roles that I play, but in recent years I have been trying to scale back the time away and do more maintenance and compliance.”
Despite the challenges that come with a career in the transport industry, Caleb would still encourage other young people to give it a chance.
“Obviously if you want to make the big money, it comes with sacrifices,” he said.
“But if you’re a young person looking for a career where you can travel the country and get paid well for it, I think it’s a great option.
“There are a lot of positives to the industry and some amazing people who help

you along the way.”
Caleb said he was delighted to win the Young Driver of the Year award, which was presented at the LRTAV conference in Shepparton last month (see pages 42-43), and admits his attention to detail may have helped him claim the trophy.
fort into finding out as much as I can about it,” he said.
“That way I can be better informed to make decisions.”
Sharing his advice for new truckies, he said: “You’re not just driving a truck, you’ve got to really put your mind to it, take your time and do the job well. Learn from more senior drivers and work your

73 Formation St, Wacol
Easter Group, located in Wacol, provides time sensitive road transporting solutions to many companies throughout Queensland, New South Wales, South Australia and Victoria.
We are a family owned business, operating since 1976. We currently have the following positions available: OPERATIONS ALLOCATORS (Brisbane based only)
You will be required to work on a rotating roster including Days-Nights-Weekends
Previous Operations experience preferred.

(Brisbane, Sydney, Melbourne and Adelaide Based)
Come and work for us as we are committed to:
• Training and further education • Your safety
• Maintaining an impressive Fleet
On offer are permanent full time and roster positions including paid leave entitlements and public holidays. Drivers will need to be available to be scheduled for work falling across the 7 days of the week.
The successful Applicant will:
• Hold a current MC licence (minimum two years) • Have knowledge of the HVNL and Load Restraint • Be professional • Be reliable
To apply for the Operations/Driver positions please contact Operations Manager or by emailing your resume to
MECHANICS & TYRE FITTERS WANTED (Brisbane based only)
To apply for Mechanic positions please forward your resume to Workshop Manager via email to employment@kseaster.com.au



